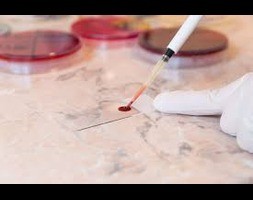
services-thumb
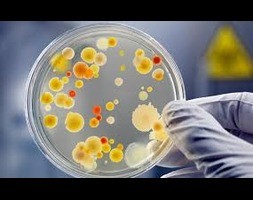
services-thumb
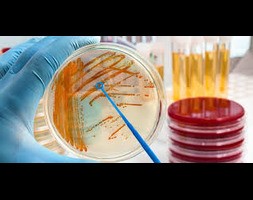
services-thumb

Original Price: Rs. 800
Discounted Price: Rs. 499
Complete hemogram is a test that measures the number of RBCs, WBCs and platelets in blood it also measures the rate at which the RBCs sediment, commonly known as the erythrocyte sedimentation rate (ESR).

Original Price: Rs. 1200
Discounted Price: Rs. 1000
Thyroid tests tell your healthcare provider how well your thyroid gland works. These tests can help diagnose conditions like hyperthyroidism, hypothyroidism, Graves’ disease, Hashimoto’s disease and thyroid cancer. Types of thyroid tests include blood tests, imaging tests and nuclear medicine tests.

Original Price: Rs. 2800
Discounted Price: Rs. 2200
A vitamin D test measures the level of vitamin D in your blood to make sure you have enough for your body to work well. Vitamin D is essential for healthy bones and teeth. It also helps keep your muscles, nerves, and immune system working normally.

Original Price: Rs. 1200
Discounted Price: Rs. 1000
HbA1c is a blood test that is used to diagnose type 2 diabetes. It is also used to monitor blood glucose control in people with diabetes. HbA1c is short for glycated haemoglobin. The test is also sometimes called haemoglobin A1c. Haemoglobin (Hb) is the protein in red blood cells that carries oxygen through your body.

Original Price: Rs. 1800
Discounted Price: Rs. 1600
Vitamin B12, or cobalamin, is naturally found in animal foods. It can also be added to foods or supplements. Vitamin B12 is needed to form red blood cells and DNA. It is also a key player in the function and development of brain and nerve cells.

Original Price: Rs. 900
Discounted Price: Rs. 800
Liver function tests (also called LFTs) are blood tests that provide information about how your liver is working. If your liver function tests are abnormal, further testing might be necessary to work out what is causing liver damage and/or disease.

Original Price: Rs. 900
Discounted Price: Rs. 800
Kidney function tests measure how efficiently your kidneys are working. Most of these tests check how well your kidneys clear waste from your system. A kidney test may involve a blood test, 24-hour urine sample or both. You usually have your test results the same day or within a few days.

Original Price: Rs. 900
Discounted Price: Rs. 800
A complete cholesterol test — also called a lipid panel or lipid profile — is a blood test that can measure the amount of cholesterol and triglycerides in your blood.

Original Price: Rs. 250
Discounted Price: Rs. 180
A uric acid blood test may be used to: Help diagnose gout, usually when done with a synovial fluid analysis. Monitor uric acid levels in people who are having cancer chemotherapy or certain other cancer treatments. When treatment kills cancer cells quickly, they release large amounts of purines into the blood.

Original Price: Rs. 100
Discounted Price: Rs. 80
A blood glucose test measures the glucose (sugar) level in your blood. The test can involve a finger prick or a blood draw from your vein. Healthcare providers most commonly use blood glucose tests to screen for Type 2 diabetes, which is a common condition. Too much or too little glucose in the blood can indicate a serious medical condition. High blood glucose levels (hyperglycemia) may be a sign of diabetes, a disorder that can cause serious, long-term health conditions.

Original Price: Rs. 1800
Discounted Price: Rs. 1500
An insulin in blood test measures the amount of insulin in a sample of your blood. Insulin is a hormone that your pancreas makes. It helps move blood glucose (blood sugar) from your bloodstream into your cells where it's used for energy. Glucose comes from many foods you eat. It's your body's main source of energy.

Original Price: Rs. 350
Discounted Price: Rs. 300
A calcium blood test measures the amount of calcium in your blood. If there is too much or too little calcium in the blood, it may be a sign of a wide range of medical conditions, such as bone disease, thyroid disease, parathyroid disorders, kidney disease, and other conditions. Calcium is one of the most important minerals in your body. About 1% of the calcium in your body is in your blood. The rest is stored in your bones and teeth. Having the right amount of calcium in your blood is necessary for your nerves, muscles, and heart to work properly. It also helps blood vessels move blood throughout your body and helps release hormones that affect many body functions. Other names: total calcium, ionized calcium

Original Price: Rs. 1800
Discounted Price: Rs. 1600
This test measures the level of C-peptide in a sample of your blood or urine (pee). Measuring C-peptide is an accurate way to find out how much insulin your body is making. Insulin is a hormone that your pancreas makes. It helps blood glucose (blood sugar) get into your cells, where it can be used for energy. This helps keep your blood glucose at healthy levels. During the process of making insulin, your pancreas produces C-peptide. C-peptide and insulin enter your bloodstream at the same time and in equal amounts. C-peptide doesn't affect your blood glucose levels, but it stays in your blood longer than insulin, so it's easier to measure accurately. A C-peptide test can provide important information to help understand, monitor, and/or treat disorders that involve how well your body makes insulin, such as hypoglycemia (low blood sugar) and diabetes. Insulin is a hormone that your pancreas makes. It helps blood glucose (blood sugar) get into your cells, where it can be used for energy. This helps keep your blood glucose at healthy levels. During the process of making insulin, your pancreas produces C-peptide. C-peptide and insulin enter your bloodstream at the same time and in equal amounts. C-peptide doesn't affect your blood glucose levels, but it stays in your blood longer than insulin, so it's easier to measure accurately. A C-peptide test can provide important information to help understand, monitor, and/or treat disorders that involve how well your body makes insulin, such as hypoglycemia (low blood sugar) and diabetes. Other names: insulin C-peptide, connecting peptide insulin, proinsulin C-peptide

Original Price: Rs. 800
Discounted Price: Rs. 600
An amylase test measures the amount of amylase in your blood or urine (pee). Amylase is an enzyme, or special protein, that helps you digest carbohydrates. Most of the amylase in your body is made by your pancreas and salivary glands. A small amount of amylase in your blood and urine is normal. But having too much or too little may be a sign of a disorder of the pancreas or salivary glands, or another medical condition. Other names: Amy test, serum amylase, urine amylase

Original Price: Rs. 800
Discounted Price: Rs. 700
Lipase is a type of digestive enzyme or "digestive juice." It helps your body digest fats. Most of your lipase is made in your pancreas, an organ located behind the lower part of your stomach. Lipase is also made in your salivary (spit) glands and in your stomach. It's normal to have a small amount of lipase in your blood. But if the cells of your pancreas are damaged, they will release larger amounts of lipase. So high levels of lipase in your blood may mean you have pancreatitis, (an inflamed, swollen pancreas) or another type of pancreatic disease. A lipase tests can help diagnose these conditions and others. Other names: serum lipase, lipase, LPS

Original Price: Rs. 1500
Discounted Price: Rs. 1200
An ANA test is a blood test that looks for antinuclear antibodies in your blood. Antibodies are proteins that your immune system makes to fight foreign substances, such as viruses and bacteria. But an antinuclear antibody attacks your own healthy cells instead. It's called "antinuclear" because it targets the nucleus (center) of the cells. It's normal to have a few antinuclear antibodies in your blood. But a large number may be a sign of an autoimmune disorder. If you have an autoimmune disorder, your immune system attacks the cells of your organs and tissues by mistake. These disorders can cause serious health problems. Other names: antinuclear antibody panel, fluorescent antinuclear antibody, FANA, ANA, ANA reflexive panel

Original Price: Rs. 800
Discounted Price: Rs. 600
An HIV test checks a sample of your blood to see whether you are infected with HIV (human immunodeficiency virus). HIV is a virus that destroys certain cells in your immune system. These cells protect your body against diseases from germs, such as bacteria and viruses, and fungi. If you lose too many immune cells, your body will have trouble fighting off infections and other diseases. HIV is spread through contact with blood and other body fluids from a person who has an HIV infection. This usually happens during sex or when sharing needles or other items used to inject drugs. HIV is the virus that causes AIDS (acquired immunodeficiency syndrome). AIDS is the final, most serious stage of an HIV infection. Without treatment, HIV gradually destroys your immune system, which leads to AIDS. With AIDS, your body has trouble fighting off infections from germs that usually don't cause problems in healthy people. These are called opportunistic infections, and they can become life-threatening. AIDS increases your risk of developing certain cancers, too.

Original Price: Rs. 800
Discounted Price: Rs. 600
Hepatitis C is a viral disease triggered by an infection of the hepatitis C virus (HCV). If not recognized or treated, it can escalate into a chronic condition causing inflammation and possible liver damage. There are often no symptoms, so hepatitis C testing is critical. Screening will help determine HCV from other hepatitis causes, including hepatitis A and hepatitis B. An HCV antibody test can detect if you have been infected. It looks for antibodies to HCV in the blood. If you are 18 or older, it is a good idea to get screened at least once for Hepatitis C. Testing is also recommended during pregnancy or if you have risk factors for HCV infection. Because acute hepatitis C often has no symptoms, screening is an important way to diagnose hepatitis C before it causes liver damage.

Original Price: Rs. 500
Discounted Price: Rs. 400
This test looks for hepatitis B surface antigens in your blood. The test is used to find out whether you have a recent or long-standing infection from the hepatitis B virus (HBV). Most people with hepatitis B have no symptoms and do not know they are infected. However, HBV can cause chronic liver disease, including cirrhosis and liver cancer. HBV has proteins called antigens on its surface that cause your immune system to make antibodies. Hepatitis B surface antigens can be found in your blood within several weeks after the infection starts. They are one of the earliest signs of a hepatitis B infection. HBV is 1 of 5 hepatitis viruses. The others are hepatitis A, C, D, and E. Most hepatitis infections are caused by these 5 viruses. HBV is spread through blood, seminal fluid, and vaginal secretions. It can take several months to develop symptoms of hepatitis B after you become infected. The virus causes an infection in the liver. In most cases, this virus clears up on its own within 6 months. But in a small portion of adults and a larger portion of children, the virus doesn't go away. This is especially true for newborns. This is called having a chronic infection. It may lead to liver cell damage, scarring, cirrhosis, or liver cancer. Hepatitis B surface antigens are an early sign of an acute infection, and they are also present during chronic, or long-term, infection.

Original Price: Rs. 400
Discounted Price: Rs. 300
Syphilis is a sexually transmitted disease (STD) caused by the bacteria Treponema pallidum. Infection is spread through contact with a syphilic sore, also called a chancre, usually during vaginal, anal, or oral sex. Syphilis can also be spread from a parent to a fetus in pregnancy or to an infant during childbirth. If not treated appropriately, syphilis may cause severe damage to internal organs. Testing for syphilis is used if you have symptoms suggestive of this infection. Syphilis testing is also recommended to screen for the disease in certain groups of people at an increased risk of infection or of transmitting the infection to others. Syphilis testing can be conducted using a sample of blood, a swab of fluid taken from a sore, or a sample of spinal fluid.

Original Price: Rs. 800
Discounted Price: Rs. 600
Treponema Pallidum Hemagglutination (TPHA) test is used to detect antibodies in the blood against syphilis, which is a sexually transmitted disease. Syphilis is caused by bacteria, namely, “Treponema pallidum”. It spreads if a person comes in direct contact with a syphilitic lesion (chancre). It has three possible stages which include primary syphilis, secondary syphilis, and late or tertiary syphilis.

Original Price: Rs. 450
Discounted Price: Rs. 400
A calcium in urine test measures the amount of calcium in your urine (pee). If your urine calcium levels are too high or too low, it may be a sign of kidney disease, kidney stones, bone disease, a parathyroid gland disorder, or other conditions. Calcium is one of the most important minerals in your body. Most of your calcium is stored in your bones and teeth. About 1% of the calcium in your body is in your blood. The right amount of calcium in your blood is necessary for your nerves, muscles, and heart to work properly. Normally, your kidneys filter out a small amount of calcium from your blood, which leaves your body in urine. Checking the amount of calcium in urine can help diagnose kidney problems and other conditions that can affect calcium levels in your blood. If you have symptoms of any of these conditions, your healthcare provider may order a calcium blood test, too.

Original Price: Rs. 450
Discounted Price: Rs. 400
A 24-hour urine collection helps diagnose kidney problems. It is often done to see how much creatinine clears through the kidneys. It's also done to measure protein, hormones, minerals, and other chemical compounds.

Original Price: Rs. 650
Discounted Price: Rs. 600
The 24-hour urine protein test checks how much protein is being spilled into the urine, which can help detect disease or other problems. Urine samples are collected in one or more containers over a period of 24 hours. The containers are kept in a cool environment and then sent to a lab for analysis. Specialists then check the urine for protein. When higher-than-normal amounts of protein are in the urine, it’s called proteinuria. This is often a sign of kidney damage and disease.

Original Price: Rs. 450
Discounted Price: Rs. 400
A phosphate in urine test measures the amount of phosphate in a urine (pee) sample that you collect over a 24-hour period. Phosphate is an electrolyte. Electrolytes are electrically charged minerals. They help control the amount of fluid and the balance of acids and bases (pH balance) in your body. Phosphate is made of the mineral phosphorous combined with oxygen. Phosphate works with the mineral calcium to build strong bones and teeth. Most of your phosphate is stored in your bones. But phosphate is in every cell of your body and it affects almost everything your cells do, including how your nerves work and how your body uses energy.

Original Price: Rs. 450
Discounted Price: Rs. 400
This test measures the amount of uric acid in a sample of your blood or urine (pee). Uric acid is a normal waste product that your body makes when it breaks down chemicals called purines. Purines come from your cells when they die. Purines are also found in many foods and beverages. Most uric acid dissolves in your blood. Your kidneys filter the uric acid out of your blood, and it leaves your body in your urine. If uric acid builds up in your blood, it can form needle-shaped crystals in and around your joints. This condition is called gout. Gout is a type of arthritis that causes painful swelling in your joints. High uric acid levels can also cause kidney stones, or kidney failure. But not everyone with high levels of uric acid will have these problems.

Original Price: Rs. 450
Discounted Price: Rs. 400
An absolute eosinophil count is a blood test that measures the number of one type of white blood cells called eosinophils. Eosinophils become active when you have certain allergic diseases, infections, and other medical conditions. These cells fight the invading bacteria, viruses and infections in your body and, in a way, are fighter cells. Your body regularly produces them in the bone marrow. If the body has an infection or disease, a higher number of eosinophils are produced. They then start moving to the affected site or organ to fight off the infection.

Original Price: Rs. 450
Discounted Price: Rs. 400
The absolute lymphocytes count is part of a complete blood count (CBC). An absolute lymphocytes count tells you the number of cells as an absolute number instead of as a percentage. Multiply your total number of white blood cells by the percentage of your white blood cells that are lymphocytes to get your absolute lymphocytes count. The absolute Lymphocyte Count test is performed on a sample of blood to measure the level of Absolute Lymphocyte Count in the blood. Lymphocytes are one of the several different types of white blood cells. White blood cells are an important part of your immune system. They help your body fight antigens, like bacteria, viruses and other toxins that make you sick. If you have a weak immune system, it means that there are not enough white cells in your bloodstream. The test is performed to detect Infectious Mononucleosis, Leukemia, Lymphoma, and tuberculosis.

Original Price: Rs. 450
Discounted Price: Rs. 400
An absolute neutrophil count may be used to check for infection, inflammation, leukemia, and other conditions. It is a measure of the number of neutrophil granulocytes, a type of white blood cell, present in the blood. These cells play a vital role in the body's immune system, primarily fighting off infections, especially bacterial infections.

Original Price: Rs. 2500
Discounted Price: Rs. 2400
The angiotensin converting enzyme (ACE) is an enzyme that converts angiotensin I to angiotensin II. Angiotensin II helps increase blood pressure by causing small blood vessels in the body to tighten or narrow. It is integral to the renin angiotesin which maintains blood pressure by regulation of fluid volume and vascular tension. Its peptidase action on the decapeptide angiotensinogen I result in the hydrolysis of a terminal histidyl leucine dipeptide and formation of the octapeptide angiotensin I, a potent vasoconstrictor that increase blood pressure.

Original Price: Rs. 2500
Discounted Price: Rs. 2400
This test measures the level of adrenocorticotropic hormone (ACTH) in a sample of your blood. A hormone is a chemical messenger in your bloodstream that controls the actions of certain cells or organs. ACTH tells your adrenal glands, two small glands that sit above your kidneys, to make another hormone called cortisol. Cortisol affects almost every organ and tissue in your body. It helps your body: Respond to stress (cortisol is sometimes called the "stress hormone") Reduce inflammation Regulate blood glucose, also called blood sugar, and metabolism (how your body uses food for energy) Control blood pressure

Original Price: Rs. 850
Discounted Price: Rs. 800
Adenosine Deaminase or ADA is an enzyme present in our body whose main function is to aid in purine metabolism. It helps in the breakdown of adenosine from our food and thereby facilitates the turnover of nucleic acids in different body tissues. Adenosine Deaminase test is to keep the immunity system developed and maintained. It is also involved in certain other minor functions such as gestation maintenance, the release of amino acids in the body, neurotransmission, and epithelial cell differentiation.

Original Price: Rs. 250
Discounted Price: Rs. 200
Acid-fast stain is a laboratory test that determines if a sample of tissue, blood, or other body substance is infected with the bacteria that causes tuberculosis (TB) and other illnesses. An acid-fast stain is a laboratory test performed on a sample of blood sputum, or phlegm urine stool bone marrow skin tissue

Original Price: Rs. 400
Discounted Price: Rs. 360
The A/G ratio test is often included as part of a comprehensive metabolic panel, a test that measures proteins and other substances in the blood. It may also be used to help diagnose kidney disease, liver disease, or nutritional problems. Albumin, which helps keep blood from leaking out of blood vessels. It also helps move hormones, medicines, vitamins, and other important substances throughout the body. Globulins, which help fight infection and move nutrients throughout the body.

Original Price: Rs. 200
Discounted Price: Rs. 180
An albumin blood test measures the amount of albumin in your blood. Low albumin levels can be a sign of liver or kidney disease or another medical condition. High levels may be a sign of dehydration. Albumin is a protein made by your liver. Albumin enters your bloodstream and helps keep fluid from leaking out of your blood vessels into other tissues. It is also carries hormones, vitamins, and enzymes throughout your body. Without enough albumin, fluid can leak out of your blood and build up in your lungs, abdomen (belly), or other parts of your body.

Original Price: Rs. 200
Discounted Price: Rs. 180
An alkaline phosphatase (ALP) test measures the amount of ALP in your blood. ALP is an enzyme found in many parts of your body. Each part of your body produces a different type of ALP. Most ALP is found in your liver, bones, kidneys, and digestive system. Abnormal levels of ALP in your blood may be a sign of a wide range of health conditions, including liver disease, bone disorders, and chronic kidney disease. But an alkaline phosphatase test alone can't identify the source of ALP in your blood, so other tests are usually needed to make a diagnosis.

Original Price: Rs. 7500
Discounted Price: Rs. 7000
An allergy blood test measures a substance called immunoglobulin E (IgE) in your blood. IgE is an antibody that your body makes. If you have allergies, you may have more IgE in your blood than normal. Allergies are a common, long-term condition that involves your immune system. Your immune system makes antibodies to fight off viruses, bacteria, and other things that can make you sick. With allergies, your immune system treats one or more harmless substances, such as pollen or peanuts, as a threat. To fight the "threat," your immune system makes IgE antibodies. This is what causes your allergy symptoms.

Original Price: Rs. 1500
Discounted Price: Rs. 1400
Alpha fetoprotein (AFP) is a protein produced by the liver and yolk sac of a fetus. AFP has no normal function in adults. The alpha fetoprotein test (AFP) is a blood test performed to measure, diagnose, or monitor fetal distress or fetal abnormalities. It can also detect some liver disorders and some cancers in adults. An AFP test is a test that is mainly used to measure the level of alpha-fetoprotein (AFP) in the blood of a pregnant person. The test checks the baby's risk for having certain genetic problems and birth defects. An AFP test is usually done between 15 and 20 weeks of pregnancy. AFP is a protein that a developing baby makes. Normally, some AFP passes from the baby into the pregnant person's blood. Certain conditions can make a baby's body release more or less AFP

Original Price: Rs. 1050
Discounted Price: Rs. 1000
Amphetamine may be detected in the urine 3-72 hrs after ingestion. The urine amphetamine screening test detects the presence of amphetamine-like compounds based on a d-amphetamine concentration of 500 ng/mL or greater. Cross-reactivity is possible with many over the counter drugs and some prescription.

Original Price: Rs. 650
Discounted Price: Rs. 600
An amylase test measures the amount of amylase in your blood or urine (pee). Amylase is an enzyme, or special protein, that helps you digest carbohydrates. Most of the amylase in your body is made by your pancreas and salivary glands. A small amount of amylase in your blood and urine is normal. But having too much or too little may be a sign of a disorder of the pancreas or salivary glands, or another medical condition.

Original Price: Rs. 6000
Discounted Price: Rs. 5500
The ANA Profile Test is a blood test that helps to diagnose autoimmune diseases, which occur when the body's immune system attacks its tissues. The ANA profile test list consists of tests designed to detect and measure these antibodies, providing crucial insights into possible underlying autoimmune conditions. Antibodies are proteins that your immune system makes to fight foreign substances, such as viruses and bacteria. But an antinuclear antibody attacks your own healthy cells instead. It's called "antinuclear" because it targets the nucleus (center) of the cells.

Original Price: Rs. 2600
Discounted Price: Rs. 2500
Antineutrophil cytoplasmic antibodies (ANCA) in a sample of your blood. Antibodies are proteins that your immune system makes to fight foreign substances, such as viruses and bacteria. But sometimes antibodies attack the healthy cells of your own tissues and organs by mistake. This is called autoimmune disease. ANCAs attack healthy white blood cells called neutrophils. This can lead to a disorder called autoimmune vasculitis. There are several types of autoimmune vasculitis, but they all cause inflammation and swelling in your blood vessels. When this happens, your blood vessels can narrow or close off. This can cause different types of serious health problems depending on which blood vessels in your body are affected. There are two main kinds of ANCA called pANCA and cANCA. Each type targets a specific protein inside white blood cells. An ANCA test can show whether you have one or both types of antibodies. This information helps your health care provider diagnose which type of autoimmune vasculitis you have so you can get the right treatment. Testing for pANCA can also help diagnose certain types of inflammatory bowel disease (IBD). IBD is a group of chronic (long-lasting) autoimmune diseases that cause swelling and irritation in your stomach and intestines.

Original Price: Rs. 2600
Discounted Price: Rs. 2500
To help detect, diagnose, and sometimes monitor certain forms of systemic vasculitis (an autoimmune disorder that causes inflammation of blood vessels) To help distinguish between Crohn disease (CD) and ulcerative colitis (UC), the two most common types of inflammatory bowel disease (IBD); as an adjunct to other IBD testing

Original Price: Rs. 4500
Discounted Price: Rs. 4000
The Antenatal Care (ANC) profile test is performed on pregnant females to assess the overall health of both the mother and the growing baby. It is usually recommended during the first trimester of pregnancy and can help identify pre-existing medical conditions or health concerns in the early stages of pregnancy. The health conditions that can be identified with the help of an ANC profile test in pregnancy include anaemia, diabetes, viral infections such as hepatitis and HIV, and more. Essentially, the ANC profile test helps detect any defects or health concerns in both the mother and the baby at an early stage, ensuring prompt treatment for the safety of both.

Original Price: Rs. 2300
Discounted Price: Rs. 2200
A CCP antibody test is used to help diagnose or rule out rheumatoid arthritis. It's often done along with or after a rheumatoid factor (RF) test. Rheumatoid factors are another type of autoantibody. RF tests used to be the main test to help diagnose rheumatoid arthritis. The immune system is responsible for defending the body against attacks from foreign cells and organisms: bacteria, viruses, parasites and transplanted cells. Often, the immune system goes awry and confuses some of its own tissues as foreign. The production of antibodies against its own tissues is the cause of a large number of “autoimmune” diseases. Several types of arthritis, lupus, pernicious anemia, juvenile diabetes and some thyroid disorders are autoimmune in origin. The immune system’s production of antibodies against its own cyclic citrullinated peptides is the cause of rheumatoid arthritis.

Original Price: Rs. 1700
Discounted Price: Rs. 1600
The anti-double stranded DNA (anti-dsDNA) tests are used to help diagnose and monitor lupus, also called systemic lupus erythematosus or SLE, a chronic inflammatory autoimmune disorder in which the immune system mistakenly targets the body's own cells and tissues.

Original Price: Rs. 3500
Discounted Price: Rs. 3000
Anti-Glomerular Basement Membrane disease (anti-GBM disease) is a disease that occurs as a result of injury to small blood vessels (capillaries) in the kidneys and/or lungs. The glomerular basement membrane is the part of the kidney that helps filter waste and extra fluid from the blood. Anti-glomerular basement membrane antibodies are antibodies against this membrane. They can lead to kidney damage. This article describes the blood test used to detect these antibodies.

Original Price: Rs. 650
Discounted Price: Rs. 600
A hepatitis C antibody test is used to find out if you are infected with the hepatitis C virus (HCV). When your body is infected with a virus, it makes antibodies to fight the virus. The hepatitis C antibody test looks for antibodies that the body makes in response to the presence of HCV. HCV infects the liver, often causing inflammation and damage. It can lead to cirrhosis, liver failure, and liver cancer. It's more common in developing nations.

Original Price: Rs. 3600
Discounted Price: Rs. 3500
AMH tests are mainly used with other tests to make decisions about treating female infertility (not being able to get pregnant). If you're having infertility treatment, AMH testing can: Check how many eggs you have left in your ovaries. This is called your "ovarian reserve.

Original Price: Rs. 2500
Discounted Price: Rs. 2400
Antithyroglobulin antibody is a test to measure antibodies to a protein called thyroglobulin. This protein is found in thyroid cells, but a small amount leaks out into the bloodstream. Sometimes the immune system produces antibodies against this protein.

Original Price: Rs. 1700
Discounted Price: Rs. 1600
The anti-TPO test is used to diagnose autoimmune diseases of the thyroid. Antibodies are proteins produced by the immune system to fight foreign substances such as bacteria or viruses. When the antibodies start attacking the body's thyroid tissues, you develop an autoimmune disorder of the thyroid.

Original Price: Rs. 500
Discounted Price: Rs. 450
The aPTT is 1 of several blood coagulation tests. It measures how long it takes your blood to form a clot. Normally, when 1 of your blood vessels is damaged, proteins in your blood called clotting factors come together in a certain order to form blood clots and quickly stop bleeding.

Original Price: Rs. 1050
Discounted Price: Rs. 1000
Antistreptolysin O (ASO) titer is a blood test to measure antibodies against streptolysin O, a substance produced by group A streptococcus bacteria. Antibodies are proteins our bodies produce when they detect harmful substances, such as bacteria.

Original Price: Rs. 1050
Discounted Price: Rs. 1000
Barbituates may be detected in the urine 1-21 days after ingestion. The urine barbiturate screening test detects the presence of the barbiturate secobarbital at a concentration of 200 ng/mL or greater. Other barbiturates are detected: call the laboratory for information regarding a specific barbiturate.

Original Price: Rs. 350
Discounted Price: Rs. 300
Bence-Jones protein urine test is used most often to diagnose and check on multiple myeloma, a type of cancer. An abnormal Bence-Jones test result may mean you have a type of malignant lymphoma. These are cancers of the lymphatic system. Multiple myeloma is a type of blood cancer that affects plasma cells

Original Price: Rs. 1500
Discounted Price: Rs. 1400
The HCG blood test is a qualitative test known as the serum or the beta HCG test. It helps to determine the HCG levels to understand whether the female is pregnant. In pregnant women, it also helps to determine the progression and well-being of the pregnancy. If the HCG levels are normal, it means the baby is healthy.

Original Price: Rs. 1700
Discounted Price: Rs. 1600
Bicarbonate test or CO2 blood test determines the amount of bicarbonate in the blood. Bicarbonate (HCO3) is gas waste left when your body burns food for energy. Your blood brings bicarbonate to your lungs and exhales as carbon dioxide (CO2).

Original Price: Rs. 3000
Discounted Price: Rs. 2800
A bile acid test is conducted to check your liver's health and measure the bilirubin level in your blood or urine. Bile acid levels serve as a marker for evaluating liver health. An increase in their levels is associated with conditions like acute or chronic hepatitis, liver sclerosis, or cancer.

Original Price: Rs. 200
Discounted Price: Rs. 180
The bilirubin blood test measures the level of bilirubin in the blood. Bilirubin is a yellowish pigment found in bile, a fluid made by the liver. Bilirubin can also be measured with a urine test. Blood is drawn from a vein (venipuncture), usually from the inside of the elbow or the back of the hand.

Original Price: Rs. 3300
Discounted Price: Rs. 3200
A biopsy is a diagnostic test in which a sample of the skin, tissue, organ, or tumor is extracted and examined to confirm the disease or illness. The sample is extracted surgically, especially for examination, or, in some cases, samples are extracted during the surgery or operation and sent for examination.

Original Price: Rs. 100
Discounted Price: Rs. 80
Bleeding time is a clinical laboratory test performed to evaluate platelet function. It involves the creation of a standardized incision and timing the cessation of bleeding. It involves the creation of a standardized incision and timing the cessation of bleeding.

Original Price: Rs. 400
Discounted Price: Rs. 350
A blood culture test helps your doctor figure out if you have a kind of infection that is in your bloodstream and can affect your entire body. Doctors call this a systemic infection. The test checks a sample of your blood for bacteria or yeast that might be causing the infection.

Original Price: Rs. 200
Discounted Price: Rs. 180
The urea test measures the urea and creatinine levels in the blood to evaluate the efficiency and functioning of the kidney. Physicians predominantly advise this test for patients suffering from chronic kidney diseases and those undergoing dialysis.

Original Price: Rs. 100
Discounted Price: Rs. 80
A blood glucose test measures the glucose levels in your blood. Glucose is a type of sugar. It is your body's main source of energy. A hormone called insulin helps move glucose from your bloodstream into your cells.

Original Price: Rs. 100
Discounted Price: Rs. 80
A postprandial glucose (PPG) test is a blood glucose test that determines the amount of glucose in the plasma after a meal. The diagnosis is typically restricted to postprandial hyperglycemia due to lack of strong evidence of co-relation with a diagnosis of diabetes.

Original Price: Rs. 100
Discounted Price: Rs. 80
A random glucose test measures the amount of glucose or sugar circulating in a person's blood. They will not need to fast before the test takes place. Doctors perform this test to determine whether a person may have diabetes.

Original Price: Rs. 100
Discounted Price: Rs. 80
Blood group ABO Rh test is a test that is done to figure out the type of blood type in a person or which blood group they belong in. Not all people have the same blood group as there are many different types, of which some are more commonly found than others.

Original Price: Rs. 3200
Discounted Price: Rs. 3000
A bone marrow test is a way of testing cells from your bone marrow. Bone marrow is the spongy tissue inside your bones that makes blood cells. A bone marrow biopsy involves removing a small sample of the bone marrow inside your bones for testing. Bone marrow is a soft tissue in the center of most large bones. It makes most of the body's blood cells. The biopsy is done using a small needle inserted into the bone.

Original Price: Rs. 350
Discounted Price: Rs. 300
A calcium blood test measures the amount of calcium in your blood. If there is too much or too little calcium in the blood, it may be a sign of a wide range of medical conditions, such as bone disease, thyroid disease, parathyroid disorders, kidney disease, and other conditions.

Original Price: Rs. 1500
Discounted Price: Rs. 1400
Carcinoembryonic antigen (CEA) test is used to check how well treatment is working in certain types of cancer, particularly bowel cancer. Carcinoembryonic antigens are proteins produced by some types of cancer. In response to the antigens, the body produces antibodies to help fight them.

Original Price: Rs. 500
Discounted Price: Rs. 400
A chloride blood test measures the amount of chloride in your blood. Chloride is a type of electrolyte. Electrolytes are electrically charged minerals that help control the amount of fluids and the balance of acids and bases (pH balance) in your body. Chloride is often measured with other electrolytes to diagnose or monitor conditions, such as kidney disease, heart failure, liver disease, and high blood pressure.

Original Price: Rs. 200
Discounted Price: Rs. 180
A cholesterol test is a blood test that measures the amount of cholesterol and certain fats in your blood. Cholesterol is a waxy, fat-like substance that's found in your blood and every cell of your body. You need some cholesterol to keep your cells and organs healthy.

Original Price: Rs. 1500
Discounted Price: Rs. 1400
Serum cholinesterase is a blood test that looks at levels of 2 substances that help the nervous system work properly. They are called acetylcholinesterase and pseudocholinesterase. Your nerves need these substances to send signals.

Original Price: Rs. 100
Discounted Price: Rs. 80
A prothrombin time (PT or PT/INR) test measures how quickly your blood clots. The results may be in seconds or, more commonly, a calculation called the International Normalized Ratio (INR). When you're bleeding, proteins called clotting or coagulation factors work together to form clots that stop blood loss.

Original Price: Rs. 1050
Discounted Price: Rs. 1000
Benzoylecgonine is the main metabolite of cocaine, formed by the liver and excreted in the urine. It is the compound tested for in most cocaine urine drug screens and wastewater screenings for cocaine use.

Original Price: Rs. 500
Discounted Price: Rs. 400
A complete blood count (CBC) is a blood test. It's used to look at overall health and find a wide range of conditions, including anemia, infection, and leukemia. A complete blood count is a common blood test that is often part of a routine checkup. Complete blood counts can help detect a variety of disorders including infections, anemia, diseases of the immune system, and blood cancers.

Original Price: Rs. 7600
Discounted Price: Rs. 7500
A comprehensive Allergy Panel aids in the discovery of antibodies to specific common inhalational substances (also known as ALLERGENS) to which your body may respond with an overactive immune system.

Original Price: Rs. 200
Discounted Price: Rs. 180
Direct bilirubin (sometimes referred to as conjugated) is the form of bilirubin which has been conjugated with glucoronic acid and is excreted in the bile. Measurement of this metabolite is of assistance in diagnosis and monitoring of the many disease states associated with raised bilirubin.

Original Price: Rs. 1650
Discounted Price: Rs. 1500
A cortisol test measures the level of cortisol in your blood, urine, or saliva to see if your levels are normal. Cortisol is a hormone that affects almost every organ and tissue in your body. Cortisol is a hormone that affects almost every organ and tissue in your body. Cortisol is made by your adrenal glands, two small glands that sit above the kidneys. A gland in your brain called the pituitary gland, makes a hormone that tells your adrenal glands how much cortisol to make. If your cortisol levels are too high or too low, it may mean you have a disorder of your adrenal glands, a problem with your pituitary gland, or a tumor that makes cortisol.

Original Price: Rs. 2000
Discounted Price: Rs. 1800
C-peptide in a sample of your blood or urine (pee). Measuring C-peptide is an accurate way to find out how much insulin your body is making. Insulin is a hormone that your pancreas makes. It helps blood glucose (blood sugar) get into your cells, where it can be used for energy. This helps keep your blood glucose at healthy levels.

Original Price: Rs. 250
Discounted Price: Rs. 200
The creatinine test measures creatinine levels in a sample of your blood and/or urine (pee). Creatinine is a normal waste product in your body. It's made when you use your muscles and some of the muscle tissue breaks down.

Original Price: Rs. 800
Discounted Price: Rs. 700
Creatine Phospho Kinase(CPK) test is done if a CPK test shows that your total CPK level is elevated. CPK isoenzyme testing can help find the exact source of the damaged tissue. CPK is an enzyme found mainly in the heart, brain, and skeletal muscle. Blood is drawn from a vein (venipuncture), usually from the inside of the elbow or the back of the hand.

Original Price: Rs. 800
Discounted Price: Rs. 700
Creatine Kinase-MB test, is a blood test that measures the level of a specific enzyme called creatine kinase-myocardial band (CK-MB) in the bloodstream. CK-MB is predominantly found in the heart muscle. This test is commonly used to diagnose heart-related conditions, particularly to assess if there has been damage to the heart muscle, during a heart attack.

Original Price: Rs. 650
Discounted Price: Rs. 600
Cytology is the exam of a single cell type, as often found in fluid specimens. It's mainly used to diagnose or screen for cancer. It's also used to screen for fetal abnormalities, for pap smears, to diagnose infectious organisms, and in other screening and diagnostic areas.

Original Price: Rs. 2000
Discounted Price: Rs. 1800
A D-dimer test is a blood test that measures D-dimer, which is a protein fragment that your body makes when a blood clot dissolves in your body. D-dimer is normally undetectable or only detectable at a very low level unless your body is forming and breaking down significant blood clots. A D-dimer test is a simple blood test that can help your healthcare provider determine if you may have a blood clotting condition.

Original Price: Rs. 1700
Discounted Price: Rs. 1500
Dengue fever is a viral infection transmitted to humans by mosquitoes that live in tropical and subtropical climates and carry the virus. Blood testing detects the dengue virus or antibodies produced in response to dengue infection.

Original Price: Rs. 2000
Discounted Price: Rs. 1800
DHEAS(DEHYDROEPIANDROSTERONE SLFATE) tests to measure levels of a steroid hormone that your body converts into estrogen and androgens (testosterone). A high test result may indicate an adrenal tumor or polycystic ovary syndrome (PCOS), while a low test result may indicate Addison’s disease. You’ll need additional tests for an accurate diagnosis.

Original Price: Rs. 1350
Discounted Price: Rs. 1200
The Coombs test checks your blood for antibodies that attack red blood cells. This test may be used to screen your blood before a procedure, such as a blood transfusion. Or, it may be used to find out if you have certain conditions, such as autoimmune hemolytic anemia.

Original Price: Rs. 4500
Discounted Price: Rs. 400
Drug abuse panel (6test) means when you take a drug, the body will eventually break it down. When this happens, it releases byproducts known as “metabolites,” which are expelled through urine. Our test looks for the presence of these metabolites in the urine. While everyone’s metabolism works differently, the detection period of drugs is usually about the same for most people. The presence of the metabolites is highly predictable and a reliable indication that the patient has recently been exposed to the drugs tested.

Original Price: Rs. 6500
Discounted Price: Rs. 6000
A drug test involves testing a biological sample, such as urine or hair, for the presence of a legal or illegal drug. There are several possible uses for a drug test, the most common of which is for pre-employment screening. The most commonly tested drugs include amphetamines, cocaine, marijuana, opioids, and PCP.

Original Price: Rs. 2500
Discounted Price: Rs. 2400
Echinococcus IGG test is performed to detect antibodies to Echinococcus species, which includes E multilocularis and E granulosus. It is also referred to as hydatidosis or hydatid disease. Echinococcus granulosus infects humans as intermediate hosts leading to Cystic Hydatid disease that affects the liver and lungs.

Original Price: Rs. 300
Discounted Price: Rs. 200
A glomerular filtration rate (GFR) test is a blood test that checks how well your kidneys are working. Your kidneys are two organs on either side of your spine near your waist. They have tiny filters called glomeruli. These filters remove waste and extra water from your blood and get rid of them through urine (pee).

Original Price: Rs. 4800
Discounted Price: Rs. 4500
An extractable nuclear antigen (ENA) panel detects the presence of one or more autoantibodies in the blood that react with proteins in the cell nucleus. These proteins are known as "extractable" because they can be removed from cell nuclei using saline. Autoantibodies are produced when a person's immune system mistakenly targets and attacks the body's tissues.

Original Price: Rs. 1500
Discounted Price: Rs. 1400
The estradiol test measures the amount of estradiol (E2), the form of estrogen made mainly by the ovaries. E2 plays a key role in the development of the female reproduction system, including the uterus, fallopian tubes, vagina, and breasts. Women have higher amounts of E2 during their reproductive years and almost none after menopause. Other estrogens include estrone and estriol. Estrone is the main estrogen made during menopause. In men, E2 is secreted in moderate amounts by the testes throughout life.

Original Price: Rs. 100
Discounted Price: Rs. 80
An erythrocyte sedimentation rate (ESR) is a blood test that that can show if you have inflammation in your body. Inflammation is your immune system's response to injury, infection, and many types of conditions, including immune system disorders, certain cancers, and blood disorders. It can also be used to help monitor these conditions. Many types of conditions cause inflammation, including arthritis, vasculitis, infection, and inflammatory bowel disease. An ESR may also be used to monitor an existing condition.

Original Price: Rs. 1500
Discounted Price: Rs. 1200
A ferritin test measures the amount of ferritin in the blood. Ferritin is a blood protein that contains iron. This test can be used to find out how much iron the body stores. It allows your body to use the iron when it needs it. A ferritin test indirectly measures the amount of iron in your blood. If a ferritin test shows that the blood ferritin level is low, it means the body's iron stores are low. This is a condition called iron deficiency. Iron deficiency can cause anemia.

Original Price: Rs. 2000
Discounted Price: Rs. 1800
Measuring folate assesses whether the body has a healthy level of this essential nutrient. Folate testing is generally performed to diagnose and monitor health conditions caused by folate deficiency. Folate testing is most commonly performed to check for a folate deficiency, which means low levels of the nutrient. Your healthcare provider may order a folate test to follow up on an abnormal blood test. Testing may also be ordered if you are experiencing symptoms that could be caused by a folate deficiency.

Original Price: Rs. 1400
Discounted Price: Rs. 1200
A follicle-stimulating hormone(FSH) test is often used with a blood test for another hormone made in the pituitary gland called luteinizing hormone (LH). These two hormones work together to control sexual development and reproduction. Blood tests to check estrogen, testosterone, and progesterone levels are also commonly used with FSH testing.

Original Price: Rs. 4500
Discounted Price: Rs. 4000
A food allergy happens when your immune system - your body's defense against germs - overreacts to a certain food as if it were harmful. If you have symptoms after eating certain foods, food allergy testing can help find out if your symptoms are caused by an allergic reaction to those foods. And it's important to find out because allergic reactions to food can be serious. Most food allergy symptoms are mild and include skin rashes and abdominal (belly) pain.

Original Price: Rs. 500
Discounted Price: Rs. 400
A thyroxine test is a blood test that helps diagnose thyroid conditions. The thyroid is a small, butterfly-shaped gland at the base of your throat. Your thyroid makes hormones that control the way your body uses energy. These hormones affect your weight, heart, body temperature, muscle strength, and even your mood. In children, thyroid hormones affect growth, too. Thyroxine, also known as T4, is a type of thyroid hormone. A T4 test measures the level of T4 in your blood. Too much or too little T4 can be a sign of thyroid disease.

Original Price: Rs. 500
Discounted Price: Rs. 400
A triiodothyronine (T3) test measures the level of T3 in a sample of your blood. It's used to help diagnose thyroid disease. Your thyroid is a small, butterfly-shaped gland at the base of your throat. It makes two hormones, T3 and T4 (thyroxine). Hormones are chemical messengers in your bloodstream that control the actions of certain cells or organs. Thyroid hormones work together to control the way your body uses energy. They affect your weight, heart, body temperature, muscle strength, and even your mood. In children, thyroid hormones affect growth, too.

Original Price: Rs. 2000
Discounted Price: Rs. 1600
The FNAC method is typically performed in an outpatient department for sampling masses, such as those observed in the neck, and breast, and diseases like lymphoma, tuberculosis, etc. It serves as the initial step in identifying the underlying cause of abnormal swellings. An aspiration cytology test is recommended when a lump is discovered in the breast or neck. This test is used to determine if the lump is cancerous. Additionally, it is employed in diagnosing thyroid disease, salivary gland disease, and lymph node disease.

Original Price: Rs. 900
Discounted Price: Rs. 700
A fungal culture test helps diagnose fungal infections. Fungal infections may happen if you are exposed to fungi (more than one fungus). Fungi are plant-like life forms, such as yeasts and molds.

Original Price: Rs. 800
Discounted Price: Rs. 700
A gamma-glutamyl transferase (GGT) test measures the amount of GGT in the blood. GGT is an enzyme found throughout the body, but it is mostly found in the liver. When the liver is damaged, GGT may leak into the bloodstream. High levels of GGT in the blood may be a sign of liver disease or damage to the bile ducts. Bile ducts are tubes that carry bile in and out of the liver. Bile is a fluid made by the liver. It is important for digestion. A GGT test can't diagnose the specific cause of liver disease. So it is usually done along with or after other liver function tests, most often an alkaline phosphatase (ALP) test. ALP is another type of liver enzyme. It's frequently used to help diagnose bone disorders and liver disease.

Original Price: Rs. 700
Discounted Price: Rs. 640
The glucose tolerance test measures the body's response to sugar, also called glucose. Another name for this test is the oral glucose tolerance test. This test can be used to screen for type 2 diabetes or prediabetes before you have symptoms of either condition. Or it can help find out whether diabetes is causing existing symptoms. More often, a version of the test is used to check for diabetes that happens during pregnancy. That condition is called gestational diabetes.

Original Price: Rs. 100
Discounted Price: Rs. 80
The glucose challenge test, also called the one-hour glucose tolerance test, measures the body's response to sugar, called glucose. The glucose challenge test is done during pregnancy. This test aims to check for diabetes that develops during pregnancy. That condition is called gestational diabetes. The test is done in two steps. The first is drinking a sugary drink. One hour later, blood sugar is measured. The results show whether gestational diabetes might be present. If the test results fall outside the standard range, more testing may be needed to diagnose gestational diabetes.

Original Price: Rs. 100
Discounted Price: Rs. 80
A glucose screening test is a routine test during pregnancy that checks a pregnant woman's blood glucose (sugar) level. Gestational diabetes is high blood sugar (diabetes) that starts or is found during pregnancy.

Original Price: Rs. 400
Discounted Price: Rs. 360
Globulins are a group of proteins in your blood. They are made in your liver by your immune system. Globulins play an important role in liver function, blood clotting, and fighting infection. There are different types of globulins called alpha, beta, and gamma globulins.

Original Price: Rs. 2500
Discounted Price: Rs. 2400
Reproductive processes are regulated by hormones called gonadotrophins. These hormones are present in both men and women. The hormones in this group are follicle-stimulating hormone (FSH), Luteinising hormone (LH), and human chorionic gonadotropin (HCG). The exogenous administration of these hormones allows controlled stimulation of follicle development and ovulation and is very useful in assisted reproduction treatments to improve the outcome of the process.

Original Price: Rs. 300
Discounted Price: Rs. 200
A Gram stain test is a test used to help identify bacteria. The tested sample can be taken from body fluids that do not normally contain bacteria, such as blood, urine, or cerebrospinal fluid. A sample can also be taken from the site of a suspected infection, such as the throat, lungs, genitals, or skin. A Gram stain is a laboratory test that checks for bacteria at the site of a suspected infection or in certain bodily fluids. A medical laboratory scientist processes the Gram stain, which gives relatively quick results, so healthcare providers can know if bacteria are present, and, if so, the general type(s). This can help guide further identification tests and treatment options.

Original Price: Rs. 200
Discounted Price: Rs. 150
A hemoglobin test is a blood test. It measures the amount of a protein in red blood cells called hemoglobin. Hemoglobin carries oxygen to the body's organs and tissues when you breathe in. Then it carries the waste gas carbon dioxide back to the lungs to be breathed out. If a hemoglobin test shows that your hemoglobin level is lower than it should be, that's a sign of a condition called anemia. Causes of anemia include low levels of certain nutrients, blood loss and some long-term diseases. If a hemoglobin test shows a higher than typical level, that also could be due to various causes. Together, these causes are named erythrocytosis. The causes of erythrocytosis can be due to issues that are not cancer. These include living at a high altitude, smoking, sleep apnea, inherited hemoglobin conditions, and dehydration. Erythrocytosis can happen due to a type of bone marrow cancer called polycythemia vera.

Original Price: Rs. 2000
Discounted Price: Rs. 1800
HAV IgM test for antibodies in your blood. The test can find out if you are infected with the hepatitis A virus (HAV). Hepatitis is an inflammation of your liver, often caused by an infection. Most hepatitis infections are caused by 1 of 5 viruses: hepatitis A, B, C, D, or E. Because the symptoms of all of these infections are similar, this blood test can tell your healthcare provider which type of virus you may have. Your immune system makes antibodies when you are first infected with HAV. It can take 14 to 50 days to develop symptoms of hepatitis A after you become infected. The average time to get symptoms after you are infected is 30 days. Antibodies often begin to appear in your blood 5 to 10 days before you start having symptoms. They can stay in your blood for about 6 months after the infection. Some antibodies called IgG can last in your blood for life.

Original Price: Rs. 2000
Discounted Price: Rs. 1800
Hepatitis B is the most common serious liver infection in the world. It is caused by the hepatitis B virus that attacks and injures the liver. Two billion people (or 1 in 3) have been infected and about 300 million people are living with a chronic hepatitis B infection. Each year up to 1 million people die from hepatitis B despite the fact that it is preventable and treatable. Hepatitis B is transmitted through direct contact with infected blood or certain bodily fluids. The virus is most commonly transmitted from an infected pregnant person to their baby during childbirth, due to the blood exchange that happens between mother and baby. It is also transmitted through unsterile medical or dental equipment, unprotected sex, or unsterile needles, or by sharing personal items such as razors, toothbrushes, nail clippers, and body jewelry.

Original Price: Rs. 2000
Discounted Price: Rs. 1800
HBeAg (Hepatitis B e-Antigen) is a viral protein made by the hepatitis B virus and is released from the infected liver cells into the blood. This test detects how much virus is in the blood as a result of very active viral replication.

Original Price: Rs. 2000
Discounted Price: Rs. 1800
The HBeAB test is to screen for the presence of hepatitis B antibodies. This test is helpful in the detection of active hepatitis B infection. Hence, this test is useful in patients diagnosed with hepatitis B infection to identify if they have an active infection. This test is done in conjugation with the hepatitis Be Antigen test. In case of any active infection, levels of hepatitis B antigens will be high and adverse for Be antibodies. After successful treatment, the hepatitis B antigen test will be negative and the hepatitis B antibodies test will be positive. Those with latent hepatitis must undergo the HbeAb test at least twice a year. This helps in the early identification of the reactivation of the virus.

Original Price: Rs. 2000
Discounted Price: Rs. 1800
A "positive" or "reactive" anti-HBs (or HBsAb) test result indicates that a person is protected against the hepatitis B virus. This protection can be the result of receiving the hepatitis B vaccine or successfully recovering from a past hepatitis B infection. This test is not routinely included in blood bank screenings. A positive anti-HBs (or HBsAb) test result means you are “immune” and protected against the hepatitis B virus and cannot be infected. You are not infected and cannot spread hepatitis B to others.

Original Price: Rs. 1200
Discounted Price: Rs. 1000
A "positive" or "reactive" HBsAg test result means that the person is infected with hepatitis B. This test can detect the actual presence of the hepatitis B virus (called the “surface antigen”) in your blood. If a person tests “positive,” then further testing is needed to determine if this is a new “acute” infection or a “chronic” hepatitis B infection. A positive HBsAg test result means that you are infected and can spread the hepatitis B virus to others through your blood.

Original Price: Rs. 500
Discounted Price: Rs. 400
A "positive" or "reactive" HBsAg test result means that the person is infected with hepatitis B. This test can detect the actual presence of the hepatitis B virus (called the “surface antigen”) in your blood. If a person tests “positive,” then further testing is needed to determine if this is a new “acute” infection or a “chronic” hepatitis B infection. A positive HBsAg test result means that you are infected and can spread the hepatitis B virus to others through your blood.

Original Price: Rs. 7700
Discounted Price: Rs. 7500
This blood test measures the amount of hepatitis B virus DNA (or viral load) in the blood of chronically infected patients. The blood is tested using a Polymerase Chain Reaction (PCR) technique that is highly sophisticated and accurate. A positive HBV-DNA level (greater than 115 copies of the virus per mL [> 20 IU/mL]) indicates that the virus is multiplying in the individual's body and the person is contagious. The test is most often used to monitor the efficacy of antiviral therapy in individuals with chronic HBV infection.

Original Price: Rs. 7700
Discounted Price: Rs. 7500
The viral load of hepatitis C refers to the amount of virus present in the bloodstream. The quantitative HCV RNA tests measure the amount of hepatitis C virus in the blood. The result will be an exact number, such as "1,215,422 IU/L." Many people refer to the quantitative measurement as the hepatitis C "viral load." Viral load tests are used to confirm active hepatitis C infection and are used during treatment to help determine response. If you have lower levels of virus in your blood when you start treatment, you may have a better chance of getting rid of the virus.

Original Price: Rs. 350
Discounted Price: Rs. 300
An HDL cholesterol test measures the amount of high-density lipoprotein (good) cholesterol in your blood. High HDL levels may lower your risk for heart disease. .

Original Price: Rs. 700
Discounted Price: Rs. 600
The LDL-Cholesterol/HDL-Cholesterol ratio is a parameter used to measure the ratio between LDL cholesterol and HDL cholesterol in the blood. LDL (low-density lipoprotein) is often called "bad" cholesterol, because it can build up fatty deposits in the arteries and increase the risk of cardiovascular diseases. HDL (high-density lipoprotein), on the other hand, is known as "good" cholesterol, as it helps remove excess cholesterol from the arteries. The LDL/HDL ratio is an important measurement value used to assess the risk of cardiovascular diseases. By measuring the ratio between LDL cholesterol and HDL cholesterol, one can get an idea of a person's risk of cardiovascular disease.

Original Price: Rs. 1500
Discounted Price: Rs. 1200
The purpose of hepatitis C testing is to determine if a person has been infected by the hepatitis C virus, to evaluate a current or past infection, and to guide a patient’s treatment.

Original Price: Rs. 800
Discounted Price: Rs. 600
Hepatitis C testing is to determine if a person has been infected by the hepatitis C virus, to evaluate a current or past infection, and to guide a patient’s treatment.

Original Price: Rs. 2000
Discounted Price: Rs. 1800
Hepatitis E is inflammation of the liver caused by the hepatitis E virus (HEV). The virus has at least 4 different types: genotypes 1, 2, 3, and 4. Genotypes 1 and 2 have been found only in humans. Genotypes 3 and 4 circulate in several animals including pigs, wild boars, and deer without causing any disease, and occasionally infect humans. The virus is shed in the stools of infected persons and enters the human body through the intestine. It is transmitted mainly through contaminated drinking water. The infection is usually self-limiting and resolves within 2–6 weeks. Occasionally a serious disease known as fulminant hepatitis (acute liver failure) develops, which can be fatal.

Original Price: Rs. 1000
Discounted Price: Rs. 900
C-reactive protein (CRP) is a protein made by the liver. The level of CRP increases when there's inflammation in the body. A simple blood test can check your C-reactive protein level. A high-sensitivity C-reactive protein (hs-CRP) test is more sensitive than a standard C-reactive protein test. That means the high-sensitivity test can find smaller increases in C-reactive protein than a standard test can. The hs-CRP test can help show the risk of getting coronary artery disease. In coronary artery disease, the arteries of the heart narrow. Narrowed arteries can lead to a heart attack.

Original Price: Rs. 1500
Discounted Price: Rs. 1200
This test looks for HIV infection in your blood or saliva. Human Immunodeficiency Viruses type 1 and type 2 are etiological agents of the acquired immunodeficiency syndrome (AIDS). HIV has been isolated from patients with AIDS, AIDS related complex (ARC) and from healthy individuals at high risk for (AIDS). Infection with HIV is followed by an acute flu-like illness. This phase may remain unnoticed and the relationship to HIV infection may not be clear in many cases. Antigen to HIV can be detected throughout virtually the total infection period, starting at or shortly after the acute phase and lasting until the end stage of AIDS. Therefore, the use of highly sensitive antibody assays is the primary approach in serodiagnosis of HIV infection.

Original Price: Rs. 800
Discounted Price: Rs. 600
Human Immunodeficiency Viruses type 1 and type 2 are etiological agents of the acquired immunodeficiency syndrome (AIDS). HIV has been isolated from patients with AIDS, AIDS related complex (ARC) and from healthy individuals at high risk for (AIDS). Infection with HIV is followed by an acute flu-like illness. This phase may remain unnoticed and the relationship to HIV infection may not be clear in many cases. Antigen to HIV can be detected throughout virtually the total infection period, starting at or shortly after the acute phase and lasting until the end stage of AIDS. Therefore, the use of highly sensitive antibody assays is the primary approach in serodiagnosis of HIV infection.

Original Price: Rs. 4200
Discounted Price: Rs. 4000
HLA-B27 is a blood test to look for a protein that is found on the surface of white blood cells. The protein is called human leukocyte antigen B27 (HLA-B27). Human leukocyte antigens (HLAs) are proteins that help the body's immune system tell the difference between its cells and foreign, harmful substances. They are made from instructions by inherited genes.

Original Price: Rs. 1000
Discounted Price: Rs. 900
Helicobacter pylori (H. pylori) is a common type of bacteria that infects the lining of the stomach and the first part of the small intestine. Most people with H. pylori never have symptoms. But in some people, the bacteria can cause problems with digestion.

Original Price: Rs. 1200
Discounted Price: Rs. 1000
Helicobacter pylori (H. pylori) is a common type of bacteria that infects the lining of the stomach and the first part of the small intestine. Most people with H. pylori never have symptoms. But in some people, the bacteria can cause problems with digestion.

Original Price: Rs. 3800
Discounted Price: Rs. 3500
Human papillomavirus (HPV) is a common sexually transmitted infection. Almost all sexually active people will be infected at some point in their lives, usually without symptoms. HPV can affect the skin, genital area and throat. Condoms help prevent HPV but do not offer total protection because they do not cover all the genital skin. HPV usually goes away on its own without treatment. Some HPV infections cause genital warts. Others can cause abnormal cells to develop, which go on to become cancer. Cancers from HPV can be prevented with vaccines. The vaccine does not contain any live virus or DNA from the virus so it cannot cause cancer or other HPV-related illnesses. The HPV vaccine is not used to treat HPV infections or diseases caused by HPV, but instead to prevent the development of cancers. Currently, cervical cancer is the only HPV-caused cancer for which screening tests are available. Screening tests are used to check for disease when there are no symptoms. The goal of screening for cervical cancer is to find precancerous cell changes before they become cancer and when treatment can prevent cancer from developing. Screening for cervical cancer is an important part of routine health care for people who have a cervix. This includes women and transgender men who still have a cervix. Cervical cancer is the most common type of cancer caused by HPV, other less common cancers affecting men and women, including anal, vulvar, vaginal, mouth/throat and penile cancers.

Original Price: Rs. 1600
Discounted Price: Rs. 1500
An insulin test is a test that calculates the amount of insulin in your blood sample. As you often have to take this test after fasting, which can be between 8 to 12 hours, this test is also known as a fasting insulin test. It is used to screen for diseases like prediabetes, diabetes, and gestational diabetes.

Original Price: Rs. 1600
Discounted Price: Rs. 1500
The Insulin Post Prandial (PP) test measures the amount of insulin in your blood. Insulin is a hormone that helps move the glucose or the blood sugar from your bloodstream into your cells. This test helps measure and evaluate the insulin production by the beta cells in the pancreas. It further helps to determine the cause of low blood sugar levels or high blood sugar levels in the body as well. This test will also help the doctor to understand whether a Type 2 diabetic patient needs extra insulin or not.

Original Price: Rs. 1600
Discounted Price: Rs. 1500
An insulin random test measures the amount of insulin in your blood. Insulin is a hormone that helps move blood sugar, known as glucose, from your bloodstream into your cells. Glucose comes from the foods you eat and drink. It is your body's main source of energy.

Original Price: Rs. 2200
Discounted Price: Rs. 2000
Parathyroid hormone (PTH) testing measures the level of this hormone in your blood. PTH is made by the parathyroid glands, which are four pea-sized glands located in the neck. PTH controls the level of calcium in your blood and bones. It also helps regulate blood levels of phosphorus and vitamin D. If you have too much or too little PTH, it can cause abnormalities in blood calcium levels that may lead to serious health problems.

Original Price: Rs. 800
Discounted Price: Rs. 600
Iron is a mineral in your body that comes from foods like red meat and fortified cereals or from supplements you take. You need iron to make red blood cells. Iron is also an important part of hemoglobin, a protein in your blood that helps carry oxygen from your lungs to the rest of your body. An iron test can show if you have too much or too little of this mineral in your system. It can check for conditions like anemia, or iron overload (excess iron). Your doctor might order a test if you have symptoms of either condition.

Original Price: Rs. 6500
Discounted Price: Rs. 6000
Infertility is a disease of the male or female reproductive system defined by the failure to establish a clinical pregnancy after 12 months or more of regular unprotected sexual intercourse. Affects approximately 15% of couples worldwide who wish to conceive, which means roughly 1 in 6 couples experience some form of infertility. Genetic defects contribute significantly to infertility cases, affecting both males and females equally.

Original Price: Rs. 1400
Discounted Price: Rs. 1200
Indirect Coombs test tells your provider if there are antibodies present in your bloodstream that could attach to red blood cells. It’s used as a screening process to see how you’ll react to a blood transfusion. An indirect Coombs test is also routinely given as part of prenatal testing.

Original Price: Rs. 500
Discounted Price: Rs. 400
India ink preparation test is usually employed to detect the presence of microorganisms, particularly yeast, in a body fluid. It includes negative staining by creating a black, semi opaque background that makes the capsule of the yeast visible. One drop of cerebrospinal fluid is mixed with a drop of India ink on a clean micro slide. A cover slip is placed over it and the sample is examined through the lower lens and then through the high power lens, of a microscopic. The preparation can be diluted with a small drop of water if it to dark and murky

Original Price: Rs. 4900
Discounted Price: Rs. 4800
The Interferon Gamma Release Assay (IGRA) is a blood test used to see whether a person has been infected with Mycobacterium tuberculosis ( the bacteria causing TB). The IGRA test works by measuring the body’s immune response to the TB bacteria. An IGRA test may be used to diagnose latent TB infection. It is not used to test for active TB disease. A negative IGRA means that you probably don’t have the TB bacteria in your body. A positive IGRA test means that at some point in time, you have probably been infected with the TB bacteria. This is called latent TB infection.

Original Price: Rs. 2200
Discounted Price: Rs. 2000
Iron is one of the essential minerals in the body since it is needed to make red blood cells or RBCs. These RBCs are responsible for carrying oxygen to the lungs to the entire body. Too little or too much iron can cause various health problems. While having too much iron can cause toxicity and organ damage, iron deficiency can lead to anemia which pushes the heart to pump more blood to compensate for the lack of oxygen in the blood. An Iron Profile Test is a simple blood test that evaluates different parameters related to metabolism in the body. It finds out the level of various iron-related markers, including iron serum iron total iron binding capacity(TIBC), transferrin saturation, and ferritin. These makers tell about the iron deficiency or excess as well as the body's ability to store and utilize iron efficiently.

Original Price: Rs. 900
Discounted Price: Rs. 800
A lipase test is a blood test that measures the level of a digestive enzyme called lipase in your blood. It may also be referred to as a serum lipase or LPS. Lipase is a type of digestive enzyme that helps your body absorb fats. Your pancreas -- a long, flat organ between your stomach and spine -- makes most of the lipase in your body. Your salivary, or spit, glands and your stomach also make some. Your blood normally contains some lipase. It may contain more than usual if you have a problem with your pancreas. Your doctor may want to find out the level of this protein in your blood to find out how your pancreas is doing.

Original Price: Rs. 1400
Discounted Price: Rs. 1200
A luteinizing hormone test measures how much luteinizing hormone (LH) is in your blood. LH helps your reproductive system: specifically, a woman’s ovaries and a man’s testes. It’s also called lutropin and interstitial cell-stimulating hormone. It’s made in your pituitary gland, which is about the size of a pea and sits just behind your nose.

Original Price: Rs. 550
Discounted Price: Rs. 400
Low-density lipoprotein (LDL) cholesterol is often called the “bad” cholesterol because it collects in the walls of your blood vessels, raising your chances of health problems like a heart attack or stroke. But cholesterol isn't all dangerous. Your body needs it to protect its nerves and make healthy cells and hormones. Some cholesterol comes from the food you eat, and your liver makes more. It won’t dissolve in blood, so proteins carry it where it needs to go. These carriers are called lipoproteins. LDL is a tiny blob made up of an outer rim of lipoprotein with a cholesterol center.

Original Price: Rs. 2000
Discounted Price: Rs. 1800
The Liquid-Based Cytology (LBC) test is a modern method for preparing cervical samples for cytological examination, offering advantages over traditional smear preparations. Unlike conventional smears, LBC involves collecting cervical samples using a brush and suspending them in a liquid medium. This technique enhances specimen quality and has shown improved performance in detecting cervica cancer. LBC is often used in conjunction with Human Papillomavirus (HPV) testing for a more accurate diagnosis. Studies have indicated that LBC, compared to conventional methods, reduces the number of inadequate samples and provides a thin layer of representative cells for more accurate analysis. The LBC test has become a valuable tool in cervical screening, offering improved sensitivity and efficiency.

Original Price: Rs. 800
Discounted Price: Rs. 600
Lactate dehydrogenase (LDH) is an enzyme required during the process of turning sugar into energy for your cells. LDH is present in many kinds of organs and tissues throughout the body, including the liver, heart, pancreas, kidneys, skeletal muscles, lymph tissue, and blood cells. When illness or injury damages your cells, LDH may be released into the bloodstream, causing the level of LDH in your blood to rise. High levels of LDH in the blood point to acute or chronic cell damage, but additional tests are necessary to discover its cause. Abnormally low LDH levels only rarely occur and usually aren’t considered harmful.

Original Price: Rs. 450
Discounted Price: Rs. 300
KOH WET MOUNT is a rapid test used to visualize the fungal structures in clinical samples using potassium hydroxide (KOH) as a clearing reagent. Microscopic observation of fungal structure is an important method to identify fungal species. In clinical laboratories, microscopic observations of clinical specimens are performed to reveal the presence of fungi together with their structure before culturing or subjecting the specimen to any testing methods of fungal identification. India ink preparation, Giemsa staining, periodic-acid-Schiff staining, Grocott’s methenamine silver stain staining, calcofluor mount, and KOH mount are routinely used in diagnostic labs for microscopic examination of clinical specimens. Mycoses are rapidly diagnosed by observing the presence of fungal pathogens in a clinical sample. This will guide the microbiologist about fungal morphology and help in making presumptive identification of fungal genera and also help to determine the need for culture and types of culture media to be used. Being the easiest, simplest, and cheapest fungal observation technique, it is widely used in diagnostic laboratories.

Original Price: Rs. 1000
Discounted Price: Rs. 800
Liver function tests are blood tests used to help find the cause of your symptoms and monitor liver disease or damage. The tests measure the levels of certain enzymes and proteins in your blood. Some of these tests measure how well the liver is performing its regular functions of producing protein and clearing bilirubin, a blood waste product. Other liver function tests measure enzymes that liver cells release in response to damage or disease. Irregular liver function test results don't always mean liver disease. A member of your healthcare team will typically explain your results and what they mean.

Original Price: Rs. 200
Discounted Price: Rs. 120
Mean corpuscular hemoglobin (MCH) is a measurement of the average amount of hemoglobin in each red blood cell. Hemoglobin is a protein in red blood cells that carries oxygen from your lungs to organs and tissues of your body. An MCH test is one part of a panel of tests called the red blood cell (RBC) indices, which evaluate different characteristics and functions of red blood cells. MCH is a useful measurement for understanding how effectively oxygen is being distributed throughout the body. Changes in MCH or other RBC indices may be a sign of a blood disorder called anemia.

Original Price: Rs. 200
Discounted Price: Rs. 120
Mean corpuscular hemoglobin concentration (MCHC) is a measurement of the average amount of hemoglobin in a single red blood cell (RBC) as it relates to the volume of the cell. Hemoglobin is a protein in red blood cells that carries oxygen throughout the body, supporting the development and function of organs and tissues. The MCHC test is one of a panel of tests called the RBC indices, which help to define different physical characteristics of RBC. As an assessment of the blood’s ability to carry oxygen, the MCHC test (along with the other RBC indices) can be used to diagnose and classify disorders that affect the blood, like anemia.

Original Price: Rs. 200
Discounted Price: Rs. 120
Mean corpuscular volume (MCV) is a value calculated during a routine blood test called a complete blood count (CBC). MCV measures the average size of your red blood cells. Your red blood cells carry oxygen throughout your body. This oxygen, in turn, powers your cells. The characteristics of your red blood cells — including size — provide information about how successfully they can transport oxygen. An MCV blood test is helpful because having a large number of atypically large or atypically small red blood cells can indicate certain conditions. It’s less helpful if you have a wide variety of red blood cell sizes in a blood sample. In that case, even if there’s an abnormality, the numbers may average out as normal. An MCV is routinely performed by an automated machine on all CBCs. It’s included in the portion of the CBC that provides information on your red blood cells in particular, called the RBC (red blood cell) indices.

Original Price: Rs. 800
Discounted Price: Rs. 600
A magnesium blood test measures the amount of magnesium in a sample of your blood. Magnesium is a mineral that you get from many kinds of foods you eat. Some examples include nuts, seeds, beans, fortified breakfast cereals, green leafy vegetables, and milk. Your body needs magnesium to help your muscles, nerves, and heart work properly. Magnesium also helps control blood pressure and blood glucose, also called blood sugar. It's important for building strong bones, and it supports your immune system. Magnesium is a type of electrolyte. Electrolytes are electrically charged minerals. They help control the amount of fluid and the balance of acids and bases (pH balance) in your body. Most of your body's magnesium is stored in your bones, organs, and other body tissue. Only a small amount is found in your blood.

Original Price: Rs. 800
Discounted Price: Rs. 600
Malaria is a serious disease caused by a parasite. Malaria parasites are tiny single-celled life forms. They live and reproduce in the red blood cells of humans. This destroys the red blood cells, which makes you sick. In most cases, people get malaria when they are bitten by mosquitos that are infected with the parasite. At first, malaria symptoms may be much like the flu. In certain cases, the disease can become life-threatening if it isn't treated quickly. But medicines can usually cure malaria. Malaria tests look for signs of a malaria infection in a sample of your blood. The tests can diagnose malaria early so the disease can be cured before it causes serious illness. Malaria testing is used if you have symptoms of malaria and you have recently been in parts of the world where malaria is common.

Original Price: Rs. 450
Discounted Price: Rs. 300
Malaria is a serious disease caused by a parasite. Malaria parasites are tiny single-celled life forms. They live and reproduce in the red blood cells of humans. This destroys the red blood cells, which makes you sick. In most cases, people get malaria when they are bitten by mosquitos that are infected with the parasite. At first, malaria symptoms may be much like the flu. In certain cases, the disease can become life-threatening if it isn't treated quickly. But medicines can usually cure malaria. Malaria tests look for signs of a malaria infection in a sample of your blood. The tests can diagnose malaria early so the disease can be cured before it causes serious illness. Malaria testing is used if you have symptoms of malaria and you have recently been in parts of the world where malaria is common.

Original Price: Rs. 200
Discounted Price: Rs. 120
A Mean platelet volume blood test measures the average size of your platelets. Platelets (thrombocytes) are blood cells made in the spongy tissue inside of your bone called bone marrow. They help your blood clot. If you’re injured, platelets clump together at the site of the wound. They slow and then stop the blood flow, so you don’t lose too much blood. An MPV test calculates the average platelet size in a blood sample to get a clearer picture of the health of these blood cells. Abnormal results may signal a blood disorder or condition that affects your bone marrow.

Original Price: Rs. 1000
Discounted Price: Rs. 900
The microalbumin test is a diagnostic test used to detect small quantities of albumin in the blood. The level detected is so minute that the regular urine test cannot detect it. Albumin is a protein made in the liver that helps in retaining fluid in the blood so that it does not leak into other tissues. It also transports substances such as vitamins, hormones, and enzymes through the body. The presence of albumin in urine indicates early signs of kidney damage in people who are at risk of developing kidney disease. It also indicates that you are at a higher risk of heart disease. Acid-base imbalance, urinary tract infection, and blood in urine also result in the presence of blood in the urine.

Original Price: Rs. 1200
Discounted Price: Rs. 1000
Microalbumin creatinine ratio urine test is a way of checking for very small amounts of a protein called albumin in a sample of your urine (pee). Small amounts of albumin in urine, sometimes called microalbumin, may be one of the first signs of kidney disease. If you find kidney disease early, you can get treatment before it gets worse. Albumin is the main protein found in the blood. When healthy kidneys clean waste from your blood, tiny filters prevent large albumin molecules from leaving your body in urine. Normally, just a trace of albumin, or none at all, will get through the filters. But if your kidneys are damaged, larger amounts of albumin may pass into your urine. Creatinine is a normal waste product in urine that comes from daily wear and tear on your muscles. A microalbumin creatinine ratio test compares the amount of albumin to the amount of creatinine in your urine. This is a more accurate way to measure the amount of albumin in your urine.

Original Price: Rs. 1400
Discounted Price: Rs. 1200
The mycodot test is a single-visit aid in the diagnosis of tuberculosis, with good sensitivity and excellent specificity. The Mycodot test employs lipoarabinomannan (LAM) antigen which is bound to plastic combs.

Original Price: Rs. 4500
Discounted Price: Rs. 4000
Natriuretic peptides are proteins that your heart and blood vessels make. Natriuretic peptide tests measure the amount of these proteins in a sample of your blood. They are mainly used to help confirm or rule out heart failure in people who have symptoms. Heart failure is also called congestive heart failure. If you have this condition, your heart has trouble pumping enough oxygen-rich blood to meet your body's needs.

Original Price: Rs. 250
Discounted Price: Rs. 200
A fecal occult blood test looks for blood in a sample of stool. It can find tiny amounts of blood that can't be seen just by looking at the stool. The medical term for this hidden blood is occult blood. A fecal occult blood test is often shortened to FOBT. A fecal occult blood test is one option for colon cancer screening in people who don't have any symptoms. Occult blood in the stool may be a sign of cancer or polyps in the colon or rectum. Polyps are growths of cells that aren't cancers but could become cancers. Not all cancers or polyps bleed. If a fecal occult blood test finds blood, more tests may be needed to find the source of the bleeding. The fecal occult blood test only can detect if blood is present or not present. It can't find the source of the bleeding. A fecal occult blood test shouldn't be used if you have colon cancer symptoms. These symptoms may include blood in your stool or in the toilet, pain in your abdomen, and a change in bowel habits. This test also isn't used in people with a high risk of colon cancer. This includes those who have a history of colon polyps and those with a close family member who has had colon cancer. Talk with your healthcare team about your symptoms and health history if you are considering colon cancer screening. Blood in your stool means there is bleeding in the digestive tract.

Original Price: Rs. 6800
Discounted Price: Rs. 6500
Polycystic Ovary Disorder, commonly known as PCOD or Polycystic Ovary Syndrome (PCOS), is a prevalent hormonal disorder that affects women of reproductive age. It brings about an imbalance in reproductive hormones, leading to irregular menstrual cycles, fertility challenges, excessive androgen levels, the formation of multiple small cysts on the ovaries, and various other health issues. To diagnose and manage this condition effectively, medical professionals rely on the PCOD profile test, a comprehensive diagnostic tool that analyzes various hormonal and metabolic markers in a woman’s body. In this article, we will explore the significance of the PCOD profile test and its impact on women’s health.

Original Price: Rs. 800
Discounted Price: Rs. 700
A Pap smear, also called a Pap test, is a procedure to test for cervical cancer in women. A Pap smear involves collecting cells from your cervix — the lower, narrow end of your uterus that's at the top of your vagina. Detecting cervical cancer early with a Pap smear gives you a greater chance at a cure. A Pap smear can also detect changes in your cervical cells that suggest cancer may develop in the future. Detecting these abnormal cells early with a Pap smear is your first step in halting the possible development of cervical cancer.

Original Price: Rs. 200
Discounted Price: Rs. 150
A packed cell volume (PCV) test is a routine blood test that analyses and measures the proportion of red blood cells in a blood sample. It is also alternatively known as a hematocrit test and is expressed as a percentage of packed RBCs by volume in a blood sample, from which the amount of RBCs present in the body can be inferred. A packed cell volume or PCV test is a serological test that provides a comprehensive assessment of the percentage of red blood cells. The purpose of a PCV test is to assess the blood volume and the oxygen-carrying capacity of the red blood cells. A PCV test is generally ordered alongside a routine blood test (complete blood count).
Original Price: Rs. 800
Discounted Price: Rs. 600
A peripheral blood smear test is a technique healthcare providers use to examine your red and white blood cells and your platelets. Unlike some blood tests that are analyzed by a machine, healthcare providers analyze by looking at blood cells under a microscope. Your healthcare provider may order a peripheral blood smear along with a complete blood count (CBC), or if you already had CBC and it shows abnormal blood cell activity, they might order a PBS. For example, your CBC results may indicate your white blood cells, red blood cells and/or platelets appear abnormal or that you have an abnormal number of any given type of cell. A microscopic view of your cells may help your healthcare provider find out how and/or why your blood cells look abnormal or you have an abnormal number of cells. Results from a peripheral blood smear test aren’t a diagnosis. Healthcare providers make diagnoses based on your medical history, physical examination, and results from laboratory tests, like PBS.

Original Price: Rs. 350
Discounted Price: Rs. 300
The phosphorus test measures the level of phosphorus in your blood. Phosphorus is a common mineral found in the food you eat. It's also found in teeth and bones. Having a high or low level of phosphorus in your bloodstream can signal several health conditions. Most commonly, a high level of phosphorus is related to a kidney disorder. It shows that your kidneys are having difficulty clearing phosphorus from your blood. A high level of phosphorus can also mean uncontrolled diabetes and other endocrine disorders.

Original Price: Rs. 200
Discounted Price: Rs. 150
A platelet count is a quick, common test that measures how many platelets are in your blood. Platelets, or thrombocytes, are tiny blood cells that bud from cells in the bone marrow (megakaryocytes). Platelets form clots when there’s damage to a blood vessel. For example, if you cut your finger, platelets mix with clotting factors (proteins in the blood). Together, they form a “glue” that stops the bleeding. There are tens of thousands of platelets in a single drop of blood. A platelet count is usually part of a complete blood count. This test measures the number of platelets, white blood cells, and red blood cells. The bone marrow makes blood cells.

Original Price: Rs. 200
Discounted Price: Rs. 150
Platelet distribution width test measures the size differences in platelets in a person’s blood. High PDW means that there is a range of platelet sizes, and low PDW suggests more similar-sized platelets. Knowing these variations helps doctors understand how a person’s platelets are functioning.

Original Price: Rs. 250
Discounted Price: Rs. 200
A potassium blood test measures the amount of potassium in your blood. Potassium is a type of electrolyte. Electrolytes are electrically charged minerals that help control fluid levels and the balance of acids and bases (pH balance) in your body. They also help control muscle and nerve activity and perform other important functions. Your cells, nerves, heart, and muscles need potassium to work properly. Potassium levels that are too high or too low may be a sign of a medical problem. Other names: potassium serum, serum potassium, serum electrolytes, K

Original Price: Rs. 200
Discounted Price: Rs. 150
A pregnancy test can tell whether you're pregnant by checking a sample of your urine (pee) or blood for a specific hormone. The hormone is called human chorionic gonadotropin (hCG). High levels of hCG are a sign of pregnancy. hCG increases quickly in the first ten weeks after a fertilized egg attaches to the inside wall of the uterus. Urine tests for pregnancy are most accurate when you do the test a week or two after you've missed your menstrual period. If you take a urine test too close to the time you got pregnant, the test could say that you are not pregnant even when you are. That's because your body may not yet have made enough hCG to show up on the test. You can have an hCG urine test at your health care provider's office or you can do the test yourself with an at-home test kit. These tests are basically the same, so many people use a home pregnancy test before calling their provider. If you follow the instructions carefully, home pregnancy tests are about 97-99% accurate. They can give you the results in minutes.

Original Price: Rs. 2700
Discounted Price: Rs. 2500
A blood test known as the PCT checks procalcitonin. Procalcitonin is the precursor hormone to calcitonin which is synthesised in the thyroid gland. Usually, procalcitonin levels are low in a healthy person but can increase substantially after bacterial infections, especially severe ones. For a procalcitonin test, a blood sample is required. It measures the amount of a chemical known as procalcitonin that is produced by different types of cells in the body. Procalcitonin levels can be high if there is bacterial infection or any tissue damage. Therefore, in case a bacterial infection is widespread or systematic, the procalcitonin levels can spike rapidly. Other conditions too can cause an increase in procalcitonin, mostly mild to moderate. However, the elevation of procalcitonin does not mean that sepsis will occur. It is just an indication that further investigation will be needed for the nature of systemic disease to be addressed.

Original Price: Rs. 200
Discounted Price: Rs. 150
The progesterone test is used to measure the amount of progesterone in your body. Typically, this test is performed as a routine part of pregnancy monitoring, as progesterone is the hormone that helps prepare the body for pregnancy. Low progesterone levels can indicate problems in the early stages of pregnancy since the developing placenta produces this hormone in relatively large amounts. However, the test can also be used to help determine whether or not a woman has ovulated, as well as help determine the cause of abnormal uterine bleeding in non-pregnant women.

Original Price: Rs. 2800
Discounted Price: Rs. 2500
A prolactin (PRL) test measures the level of prolactin in a sample of your blood. Prolactin is a hormone produced by the pituitary gland, a small gland at the base of the brain. Hormones are chemical messengers in your bloodstream that control the actions of certain cells or organs. Prolactin affects many body processes. But its main role is to signal breast tissue to grow during pregnancy and make milk for breastfeeding after birth. So, prolactin levels in pregnant women and new mothers are normally high. In nonpregnant women and men, prolactin levels are normally low.

Original Price: Rs. 350
Discounted Price: Rs. 300
A prothrombin time (PT) test measures how many seconds it takes for a clot to form in a blood sample. Since the results of this test can vary with different labs or test methods, your results may be used to create an INR (international normalized ratio). Using this ratio makes it easier for healthcare providers to compare and better understand results from different labs or test methods. Prothrombin is a protein made by the liver. It is one of several substances known as clotting (coagulation) factors. When you get a cut or other injury that causes bleeding, your clotting factors work together to form a blood clot. Blood clotting is an important process that prevents you from losing too much blood when you are injured. Clotting factor levels that are too low can cause you to bleed too much after an injury. Levels that are too high can cause dangerous clots to form in your arteries or veins. A PT/INR test helps find out if your blood is clotting normally. It also checks to see if a medicine that prevents blood clots is working the way it should.

Original Price: Rs. 2200
Discounted Price: Rs. 2000
The prostate-specific antigen test is a blood test used primarily to screen for prostate cancer. The test measures the amount of prostate-specific antigen (PSA) in your blood. PSA is a protein produced by both cancerous and noncancerous tissue in the prostate, a small gland that sits below the bladder in males. PSA is mostly found in semen, which also is produced in the prostate. Small amounts of PSA ordinarily circulate in the blood. The PSA test can detect high levels of PSA that may indicate the presence of prostate cancer. However, many other conditions, such as an enlarged or inflamed prostate, also can increase PSA levels. Therefore, determining what a high PSA score means can be complicated. There is a lot of conflicting advice about PSA testing. To decide whether to have a PSA test, discuss the issue with your doctor, considering your risk factors and weighing your personal preferences.

Original Price: Rs. 1500
Discounted Price: Rs. 1400
PROSTRATE SPECIFIC ANTIGEN, FREE TEST The Prostrate specific antigen test is a blood test used primarily to screen for prostate cancer. The test measures the amount of prostate-specific antigen (PSA) in your blood. PSA is a protein produced by both cancerous and noncancerous tissue in the prostate, a small gland that sits below the bladder in males. PSA is mostly found in semen, which also is produced in the prostate. Small amounts of PSA ordinarily circulate in the blood. The PSA test can detect high levels of PSA that may indicate the presence of prostate cancer. However, many other conditions, such as an enlarged or inflamed prostate, also can increase PSA levels. Therefore, determining what a high PSA score means can be complicated. There is a lot of conflicting advice about PSA testing. To decide whether to have a PSA test, discuss the issue with your doctor, considering your risk factors and weighing your personal preferences.
Original Price: Rs. 500
Discounted Price: Rs. 400
The pus culture and sensitivity test is a valuable diagnostic tool that helps healthcare providers identify the specific bacteria causing an infection and determine which antibiotics are most effective in treating it. This information is crucial for guiding treatment decisions and ensuring prompt recovery.

Original Price: Rs. 5000
Discounted Price: Rs. 4800
QuantiFERON-TB Gold (QFT) is a simple blood test that aids in the detection of Mycobacterium tuberculosis, the bacteria that causes tuberculosis (TB). QFT is an interferon-gamma (IFN-γ) release assay, commonly known as an IGRA, and is a modern alternative to the tuberculin skin test (TST, PPD, or Mantoux). Unlike the TST, QFT is a controlled laboratory test that requires only one patient visit and is unaffected by previous Bacille Calmette-Guerin (BCG) vaccination. QFT is highly specific and sensitive: a positive result is strongly predictive of true infection with M. tuberculosis. However, like the TST and other IGRAs, QFT cannot distinguish between active tuberculosis disease and latent tuberculosis infection and is intended for use with risk assessment, radiography, and other medical and diagnostic evaluations. Like any diagnostic aid, QFT cannot replace clinical judgment. The US Centers for Disease Control (CDC) Guidelines recommend the use of IGRAs in all situations in which the TST was historically used, with IGRAs being the preferred test for persons who have been BCG vaccinated or are unlikely to return for TST reading (1).

Original Price: Rs. 450
Discounted Price: Rs. 300
A rheumatoid factor (RF) test looks for rheumatoid factor (RF) in a sample of your blood. Rheumatoid factors are proteins made by the immune system. Normally, your immune system makes proteins called antibodies to attack germs that could make you sick. But rheumatoid factors are antibodies that sometimes attack healthy cells and tissues in your body by mistake. When this happens, you have an autoimmune disorder. Not everyone has rheumatoid factors in their blood. And some people who have them are healthy. But if you have certain symptoms and higher levels or rheumatoid factors, you may have an autoimmune disorder or another health problem related to high RF levels. RF testing is mostly used with other tests to help diagnose rheumatoid arthritis. Rheumatoid arthritis (RA) is a type of autoimmune disorder that damages your joints and causes pain, swelling, and stiffness. It is a chronic (long-lasting) condition that can also affect your organs and cause other symptoms. High levels of rheumatoid factors may also be a sign of other autoimmune disorders, certain infections, and certain types of cancer.

Original Price: Rs. 200
Discounted Price: Rs. 150
A red blood cell (RBC) count measures the number of red blood cells, also known as erythrocytes, in your blood. Red blood cells carry oxygen from your lungs to every cell in your body. Your cells need oxygen to grow, reproduce, and stay healthy. An RBC count that is higher or lower than normal is often the first sign of an illness. So the test may allow you to get treatment even before you have symptoms.

Original Price: Rs. 850
Discounted Price: Rs. 800
Renal function tests (RFT) are a group of tests that may be performed together to evaluate kidney (renal) function. The tests measure levels of various substances, including several minerals, electrolytes, proteins, and glucose (sugar), in the blood to determine the current health of the kidneys. If the kidneys are not functioning properly, waste products can accumulate in the blood, and fluid levels can increase to dangerous volumes, causing damage to the body or a potentially life-threatening situation. Numerous conditions and diseases can result in damage to the kidneys. The most common causes of and main risk factors for kidney disease are diabetes and hypertension.

Original Price: Rs. 800
Discounted Price: Rs. 600
A reticulocyte count measures the number of immature red blood cells (reticulocytes) in your bone marrow. Healthcare providers measure reticulocytes to find out if your bone marrow is producing enough healthy red blood cells. Your bone marrow is a red blood cell production line, constantly creating and nurturing new red blood cells to replace aging and dying red blood cells. That production line goes into high gear if you need more red blood cells than usual. Measuring reticulocytes is one of the many ways healthcare providers diagnose and monitor conditions that affect your red blood cells.

Original Price: Rs. 1400
Discounted Price: Rs. 1200
The Rh (Rhesus) Antibody Titre is a blood test that is primarily used during pregnancy to determine the mother's Rh blood type (Rh positive or Rh negative) and to check whether she has developed antibodies against the Rh antigen. The Rh antigen is a protein found on the red blood cells (RBCs) of about 85% of people, and they are termed Rh positive. Those who lack the Rh antigen are referred to as Rh-negative. This is particularly important in cases where an Rh-negative woman is pregnant with an Rh-positive fetus. The immune system of the Rh-negative mother may recognize the Rh antigen on the fetal blood cells as foreign and produce antibodies against it, a process known as Rh sensitization. The Rh Antibody Titre test measures the levels of these antibodies in the mother's blood.

Original Price: Rs. 150
Discounted Price: Rs. 100
Rhesus (Rh) typing is used to find out if you have a certain protein called Rh factor on the outer layer of your red blood cells. If you don't have Rh factor in your blood, you are Rh negative. If you do have Rh factor in your blood, you are Rh-positive. Most people are Rh positive. But Rh-negative blood types can be passed down from parents to children. Rh typing is important during pregnancy. If you are Rh negative and your baby is Rh positive, you may have an Rh incompatibility. During pregnancy, it's possible that some of your baby's blood could pass through the placenta into your body. Your body may react to the baby's blood as a foreign substance and make antibodies against it. This can cause a miscarriage, anemia, and problems in later pregnancies. The first pregnancy is often not affected by Rh incompatibility because the baby is often born before many of the antibodies develop. These risks can be lowered by a shot or shots of Rh immunoglobulin during each pregnancy, miscarriage, or other instances when you may have been exposed to Rh-positive blood.

Original Price: Rs. 400
Discounted Price: Rs. 350
A semen analysis, also called a sperm count, measures the quantity and quality of semen and sperm. Semen is the thick, white fluid released from the penis during sexual climax (orgasm). This release is called ejaculation. Semen contains sperm, the cells made in the male reproductive system that include the genetic material needed to make a baby. If you and your partner haven't been able to get pregnant, a problem with semen or sperm may be one of the reasons. Problems such as a low sperm count or sperm that don't move properly can cause infertility, which is the inability to conceive a baby after a year of trying. A semen analysis can help figure out if a problem with semen or sperm is likely to be causing infertility.

Original Price: Rs. 250
Discounted Price: Rs. 200
A sodium blood test measures the amount of sodium in your blood. Sodium is a type of electrolyte. Electrolytes are electrically charged minerals. They help control the amount of fluid and the balance of acids and bases (pH balance) in your body. Sodium also helps your nerves and muscles work properly. You get most of the sodium you need in your diet. If you take in too much, your kidneys get rid of the extra sodium in your urine. Normally, your body keeps your sodium levels in a very narrow range. If your sodium blood levels are too high or too low, it may mean that you have a kidney problem, dehydration, or another type of medical condition.

Original Price: Rs. 450
Discounted Price: Rs. 400
A potassium blood test measures the amount of potassium in your blood. Potassium is a type of electrolyte. Electrolytes are electrically charged minerals that help control fluid levels and the balance of acids and bases (pH balance) in your body. They also help control muscle and nerve activity and perform other important functions. Your cells, nerves, heart, and muscles need potassium to work properly. Potassium levels that are too high or too low may be a sign of a medical problem.

Original Price: Rs. 450
Discounted Price: Rs. 400
A sputum culture is a test that checks for bacteria or another type of organism that may be causing an infection in your lungs or the airways leading to the lungs. Sputum, also known as phlegm, is a thick type of mucus made in your lungs. If you have an infection or chronic illness affecting the lungs or airways, it can make you cough up sputum. Sputum is not the same as spit or saliva. Sputum contains cells from the immune system that help fight the bacteria, fungi, or other foreign substances in your lungs or airways. The thickness of sputum helps trap the foreign material. This allows cilia (tiny hairs) in the airways to push it through the mouth and be coughed out.

Original Price: Rs. 450
Discounted Price: Rs. 400
A stool test looks for pathogens (bacteria, viruses, parasites) in your poop that can make you sick. Stool tests can also look for other signs, like hidden blood, that signal something’s wrong. Healthcare providers can use stool tests to check for a wide range of gastrointestinal (GI) issues, including infections and cancers.

Original Price: Rs. 1200
Discounted Price: Rs. 1000
Helicobacter pylori (H. pylori) is a common type of bacteria that infects the lining of the stomach and the first part of the small intestine. Most people with H. pylori never have symptoms. But in some people, the bacteria can cause problems with digestion. H. pylori is the most common cause of peptic ulcers, which are sores that form mainly in the stomach and upper part of the small intestine. H. pylori can also cause gastritis (inflammation and irritation of the stomach lining). Without treatment, H. pylori gastritis can last a lifetime and increase the chance of developing stomach cancer. Researchers aren't sure how people get the bacteria. H. pylori may be spread from person to person through contact with vomit, stool (poop), or saliva (spit) from an infected person. The bacteria may also be spread through contaminated food and water. Anyone who is exposed to H. pylori can become sick with an H. pylori infection. But H. pylori infections are most common in children. Testing for the bacteria can find out if H. pylori is causing gastritis or other conditions that cause ongoing indigestion. If so, treatment can kill the bacteria so the lining of your stomach can heal. There are different ways to test for an H. pylori infection. The most common tests use samples of your breath or stool. In certain cases, tests are done on a sample of tissue that's removed from inside your stomach.

Original Price: Rs. 100
Discounted Price: Rs. 80
A Stool routine test analyses a stool sample to detect any underlying disease or other medical condition for which you may require treatment or even hospitalization. It is used to detect any kind of harmful germs like bacteria, fungi, parasites, or viruses that may be present inside your gastrointestinal tract.

Original Price: Rs. 1500
Discounted Price: Rs. 1400
A testosterone levels test measures the amount of testosterone in a sample of your blood. Testosterone is known as a "male" sex hormone, but females have testosterone in smaller amounts. During male puberty, testosterone causes body hair, muscle growth, and a deepening voice. In adult life, it controls the sex drive, maintains muscle mass, and helps make sperm. In females, testosterone is important for the growth of bones and muscles, and healthy organs. There are different forms of testosterone in your blood that may be measured to help diagnose certain health problems. Most of your testosterone is attached to proteins. The proteins prevent your tissues from using the testosterone right away, which helps control the amount of "active" testosterone in your body. Testosterone that's not attached to proteins is called free testosterone. Free testosterone acts on your tissues.

Original Price: Rs. 2500
Discounted Price: Rs. 2400
A thyroglobulin test measures the level of thyroglobulin in a sample of your blood. Thyroglobulin is a protein that your thyroid makes. Your thyroid is a small, butterfly-shaped gland in your neck. It makes hormones that control many activities in your body, including your heart rate and how fast you burn calories from food. A thyroglobulin test is a type of tumor marker test. Tumor markers are substances made by cancer cells and/or by normal cells in response to cancer in your body. Normally, your thyroid releases small amounts of thyroglobulin into your bloodstream. Cells from common types of thyroid cancer (papillary carcinoma and follicular thyroid cancer) also release thyroglobulin. Thyroglobulin testing is not used to diagnose thyroid cancer because other thyroid diseases that aren't cancer can also affect thyroglobulin levels. But the test is useful after treatment for common thyroid cancers to see if the treatment worked. That's because the goal of treatment is to get rid of all thyroid tissue – both healthy cells and cancer cells. So, if treatment is successful, there should be little or no thyroglobulin in your blood. If thyroglobulin levels remain the same or increase, more cancer treatment may be needed.

Original Price: Rs. 150
Discounted Price: Rs. 120
A complete blood count (CBC) is a blood test. It's used to look at overall health and find a wide range of conditions, including anemia, infection, and leukemia. A complete blood count test measures the following: Red blood cells, which carry oxygen. White blood cells, which fight infection.

Original Price: Rs. 200
Discounted Price: Rs. 180
A total protein test measures the total amount of protein in the blood. It also measures the amounts of two major groups of proteins in the blood: albumin and globulin. Increased levels of Total Protein are found in dehydration, multiple myeloma, and chronic liver diseases. Decreased levels are found in renal diseases and terminal liver failure. Total Protein can be estimated in serum.

Original Price: Rs. 800
Discounted Price: Rs. 600
The total iron binding capacity test is a blood test that measures your blood’s ability (capacity) to attach (bind) to iron and carry it throughout your body. Healthcare providers use it to help diagnose iron-deficiency anemia and other iron metabolism conditions. More specifically, a TIBC test shows the amount of transferrin in your blood. Transferrin is a protein your liver makes that regulates the absorption of iron into your blood. Your body needs iron to make healthy red blood cells. Red blood cells carry oxygen from your lungs to the rest of your body. Iron is also important for healthy muscles, bone marrow, and organ function.

Original Price: Rs. 600
Discounted Price: Rs. 400
A thyroxine test is a blood test that helps diagnose thyroid conditions. The thyroid is a small, butterfly-shaped gland at the base of your throat. Your thyroid makes hormones that control the way your body uses energy. These hormones affect your weight, heart, body temperature, muscle strength, and even your mood. In children, thyroid hormones affect growth, too. Thyroxine, also known as T4, is a type of thyroid hormone. A T4 test measures the level of T4 in your blood. Too much or too little T4 can be a sign of thyroid disease.

Original Price: Rs. 600
Discounted Price: Rs. 400
A triiodothyronine (T3) test measures the level of T3 in a sample of your blood. It's used to help diagnose thyroid disease. Your thyroid is a small, butterfly-shaped gland at the base of your throat. It makes two hormones, T3 and T4 (thyroxine). Hormones are chemical messengers in your bloodstream that control the actions of certain cells or organs. Thyroid hormones work together to control the way your body uses energy. They affect your weight, heart, body temperature, muscle strength, and even your mood. In children, thyroid hormones affect growth, too.

Original Price: Rs. 800
Discounted Price: Rs. 600
The Treponema Pallidum Hemagglutination (TPHA) test is used to detect antibodies in the blood against syphilis, which is a sexually transmitted disease. Syphilis is caused by bacteria, namely, “Treponema pallidum”. It spreads if a person comes in direct contact with a syphilitic lesion (chancre). It has three possible stages which include primary syphilis, secondary syphilis, and late or tertiary syphilis.

Original Price: Rs. 200
Discounted Price: Rs. 180
A triglycerides test is a blood test that measures the amount of fat in your blood called triglycerides. High triglycerides may increase your risk of a heart attack or stroke. A triglycerides test can help you decide if you need to take action to lower your risk. Your body uses triglycerides for energy. If you eat more calories than you need, your body turns the extra calories into triglycerides and stores them in your fat cells to use later. When your body needs energy, your cells release triglycerides into your bloodstream to provide fuel for your muscles to work. If you eat more calories than you burn off, especially calories from carbohydrates, including sugary foods, and fats, you may have high triglyceride levels in your blood. A high blood triglyceride level usually doesn't cause any symptoms, but over time, it may affect your arteries and increase your risk of heart disease. Extremely high levels of triglycerides also increase the risk of acute pancreatitis in adults and children.

Original Price: Rs. 800
Discounted Price: Rs. 600
A troponin test measures the levels of troponin T or troponin I proteins in the blood. These proteins are released when the heart muscle has been damaged, such as occurs with a heart attack. The more damage there is to the heart, the greater the amount of troponin T and I there will be in the blood.

Original Price: Rs. 550
Discounted Price: Rs. 400
Thyroid stimulating hormone (TSH) test is a blood test that measures this hormone. TSH levels that are too high or too low may be a sign of a thyroid problem. The thyroid is a small, butterfly-shaped gland in the front of your neck. Your thyroid makes hormones that control how your body uses energy. Thyroid hormones affect nearly every organ in your body, including your heart. They help control your weight, body temperature, muscle strength, and even your mood. If you don't have enough thyroid hormones in your blood, many of your body functions slow down. If you have too much, many body functions speed up. Your thyroid is controlled by a gland in your brain, called the pituitary gland. The pituitary gland makes thyroid stimulating hormone (TSH). TSH tells your thyroid how much thyroid hormone it needs to make. If the thyroid hormone levels in your blood are too low, your pituitary gland makes larger amounts of TSH to tell your thyroid to work harder. If your thyroid hormone levels are too high, the pituitary gland makes little or no TSH. By measuring TSH levels in your blood, you can find out if your thyroid is making the right level of hormones.

Original Price: Rs. 5700
Discounted Price: Rs. 5500
The TSH (Thyroid-Stimulating Hormone) Antibody Receptor test is a blood test that helps study the functioning of the thyroid gland. But let us first understand the thyroid, its functions, and thyroid antibodies. The thyroid gland is a butterfly-shaped organ that sits in the front of your neck, below your Adam's Apple. It is a gland that produces hormones that play a vital role in controlling your body's functioning and metabolism.

Original Price: Rs. 250
Discounted Price: Rs. 200
The urine creatinine test measures creatinine levels in a sample of your blood and/or urine (pee). Creatinine is a normal waste product in your body. It's made when you use your muscles and some of the muscle tissue breaks down. Normally, your kidneys filter creatinine from your blood and remove it from your body in your urine. If there is a problem with your kidneys, creatinine can build up in your blood and less may be released in urine. If blood and/or urine creatinine levels are not normal, it may be a sign of kidney disease.
Original Price: Rs. 400
Discounted Price: Rs. 350
A urine culture is a test that checks your pee (urine) for bacterial or fungal (yeast) infections. “Culture” is the medical term for growing microorganisms (germs) from body fluids in a lab. Your healthcare provider will collect a sample of your pee and send it to a lab to be cultured. A urine culture test also identifies the bacteria or yeast causing the infection and lets your provider know which antibiotics will work to kill the germs. This helps your provider select the most effective treatment.

Original Price: Rs. 550
Discounted Price: Rs. 500
Calcium is an electrolyte that plays an important role in many physiological processes throughout the body. In normal health, almost all of the filtered calcium is reabsorbed in the post-glomerular nephron. Urinary calcium excretion exhibits diurnal variation, largely reflecting dietary intake. As such, a 24-hour collection is the best way to assess urine calcium status. If testing is to be carried out on a random urine specimen, the measured calcium should be corrected for urine concentration and reported as the calcium/creatinine ratio.

Original Price: Rs. 100
Discounted Price: Rs. 80
The urine routine test is a combination of tests that are performed on urine and is one of the most frequently conducted tests. It comprises the physical, chemical, and microscopic examination of urine.

Original Price: Rs. 250
Discounted Price: Rs. 200
Very-low-density lipoprotein (VLDL) cholesterol is produced in the liver and released into the bloodstream to supply body tissues with a type of fat (triglycerides). There are several types of cholesterol, each made up of lipoproteins and fats. Each type of lipoprotein contains a mixture of cholesterol, protein and triglycerides, but in varying amounts. About half of a VLDL particle is made up of triglycerides. The best way to lower your VLDL cholesterol is to lower your triglycerides. Losing weight and exercising regularly are key, and you might also want to avoid sugary food and alcohol in particular. Medications also can help.

Original Price: Rs. 2400
Discounted Price: Rs. 2200
The 25-hydroxy vitamin D test is the most accurate way to measure how much vitamin D is in your body. Vitamin D helps control calcium and phosphate levels in the body. Blood is drawn from a vein (venipuncture), usually from the inside of the elbow or the back of the hand.

Original Price: Rs. 400
Discounted Price: Rs. 350
The widal test is an advanced way to check for antibodies that your body makes against the salmonella bacteria that causes typhoid fever. It looks for O and H antibodies in a patient's sample blood (serum). This test helps detect life-threatening illnesses like typhoid fever.

Original Price: Rs. 400
Discounted Price: Rs. 300
The urine for dysmorphic RBC test detects the presence of dysmorphic red blood cells in the urine, which can be an indication of hematuria—a condition characterized by the presence of blood in the urine. The RBCs in urine can be due to a urinary tract infection, kidney infection, kidney stone, or some other causes.

Original Price: Rs. 400
Discounted Price: Rs. 300
The urine Red Blood Cell (RBC) Morphology test is a microscopic examination of urine to analyze the shape, size, and appearance of red blood cells present in the sample. This test helps to determine the source and cause of hematuria (blood in urine) by identifying whether the RBCs are originating from the kidneys or the lower urinary tract. Morphological abnormalities in RBCs can indicate various conditions such as glomerulonephritis, urinary tract infections, or kidney stones.

Original Price: Rs. 4500
Discounted Price: Rs. 4000
The 6 Panel -(MET) Methamphetamine drug test, (MOR) Morphine drug test, (THC) Marijuana drug test, (AMP) Amphetamine drug test, (COC) Cocaine drug test, and (BZD) Benzodiazepine Drug Testing device is based on the principle of specific immunochemical reaction between antibodies and antigens to analyze particular compounds in the human urine specimen. The assay relies on the competition for binding antibody between drug conjugate and free drug which may be present in the urine specimen being tested. When the Methamphetamine (MET), Morphine (MOR), Marijuana (THC), Amphetamine (AMP), Cocaine (COC), or Benzodiazepine (BZD) drug is present in the urine specimen, it competes with drug conjugate for the limited amount of antibody-dye conjugate. When the amount of the Methamphetamine (MET), Morphine (MOR), Marijuana (THC), Amphetamine (AMP), Cocaine (COC), or Benzodiazepine (BZD) drug is equal or more than the cut-off, it will prevent the binding of drug conjugate to the antibody. Therefore, a positive urine specimen on this Multi Panel Drug Test will not show a colored band on the test line zone, indicating a positive result, while the presence of a colored band indicates a negative result. A control line is present in the test window to work as procedural control. This colored band should always appear on the control line zone if the 6 Panel Drug testing device is stored in good condition and the 6 Panel Drug Test- (MET) Methamphetamine drug test, (MOR) Morphine drug test, (THC) Marijuana drug test, (AMP) Amphetamine drug test, (COC) Cocaine drug test, and (BZD) Benzodiazepine drug test is performed appropriately.

Original Price: Rs. 200
Discounted Price: Rs. 180
The test results will show measurement values for the bilirubin in your bloodstream. There are two different types of bilirubin in your bloodstream: the bilirubin that goes to your liver for processing, and the bilirubin that comes out of your liver. Your test will show these values separately, as well as your total bilirubin. It’ll usually show them as milligrams of bilirubin per deciliter of blood, or mg/dL.

Original Price: Rs. 2500
Discounted Price: Rs. 2200
The amount of 17-hydroxyprogesterone (17-OHP) in a sample of your blood. 17-OHP is a substance that your adrenal glands make. Your adrenal glands are two small organs that sit on top of each kidney. They make different types of hormones you need to stay alive and healthy. Hormones are chemical messengers in your bloodstream that control the actions of certain cells or organs. Normally, your adrenal glands use 17-OHP to make a hormone called cortisol. Cortisol helps control your energy levels, blood glucose (sugar), blood pressure, and your body's response to stress, illness and injury. A 17-OHP test helps diagnose a group of uncommon, inherited genetic disorders that affect how well your adrenal glands make cortisol. These genetic adrenal gland disorders are called congenital adrenal hyperplasia (CAH).

Original Price: Rs. 250
Discounted Price: Rs. 180
A blood urea nitrogen (BUN) test measures the amount of urea nitrogen in your blood. Urea nitrogen is a waste product. It develops when your body breaks down the protein in your foods. It forms in your liver and travels through your blood to your kidneys, which then filter it out of your blood. It leaves your body through your urine (pee).

Original Price: Rs. 1500
Discounted Price: Rs. 1200
A C3 complement blood test measures the levels of a specific type of protein in your blood (C3 proteins). As part of your immune system, C3 proteins destroy microbes (germs) that can make you sick. Sometimes, C3 proteins launch an attack against healthy cells by mistake. The results of this blood test give your healthcare provider information about how your immune system is working. By measuring the amount of C3 proteins, your healthcare provider can diagnose infection, disease, immune deficiency, and other health conditions, like autoimmune disorders. This test also helps your healthcare provider monitor treatment for autoimmune disease.

Original Price: Rs. 1500
Discounted Price: Rs. 1200
The C4 complement test is a test to measure the level of C4 proteins you have in your blood. These proteins play a role in how your immune system functions and defend your body from harmful bacteria and viruses. Monitoring your C4 protein levels can help doctors to diagnose and monitor certain chronic medical conditions. Here is what you need to know about complement component 4 proteins, who can benefit from a C4 complement blood test, and information about C4 test results.

Original Price: Rs. 1800
Discounted Price: Rs. 1500
A CA 125 test measures the amount of the protein CA 125 (cancer antigen 125) in the blood. This test may be used to monitor certain cancers during and after treatment. In some situations, the test may be used to look for early signs of ovarian cancer in people with a very high risk of the disease. A CA 125 test isn't accurate enough to use for ovarian cancer screening in general because many conditions can increase the level of this protein.

Original Price: Rs. 2200
Discounted Price: Rs. 2000
A CA 19-9 test measures the amount of a protein called CA 19-9 (cancer antigen 19-9) in a sample of your blood. CA 19-9 is a type of tumor marker. Tumor markers are substances made by cancer cells or by normal cells in response to cancer in your body. Healthy people can have small amounts of CA 19-9 in their blood. High levels of CA 19-9 are often a sign of pancreatic cancer. But high levels can also be a sign of other types of cancer or certain conditions that aren't cancer. For example, gallstones and cirrhosis of the liver can cause high CA 19-9 levels.

Original Price: Rs. 2200
Discounted Price: Rs. 2000
Cancer antigen 15-3 (CA15-3) is a protein made by a variety of cells, particularly breast cancer cells. The protein moves into the blood, where it can be measured. CA15-3 levels are higher than normal in most women with breast cancer that has spread to other parts of the body (called metastatic breast cancer). Not all types of breast cancer will cause CA 15-3 levels to rise, as some types of cancer cells don’t over-produce the antigen.

Original Price: Rs. 600
Discounted Price: Rs. 500
A chloride test measures the level of chloride in your blood or urine. Chloride is one of the most important electrolytes in the blood. It helps keep the amount of fluid inside and outside of your cells in balance. It also helps maintain proper blood volume, blood pressure, and pH of your body fluids. Tests for sodium, potassium, and bicarbonate are usually done at the same time as a blood test for chloride.

Original Price: Rs. 6500
Discounted Price: Rs. 6000
ENA or Extractable nuclear antigens are a group of antigens inside the cell nucleus against which the anti-nuclear antibodies (ANAs) react. When we see a positive ANA, it does not always mean lupus. An ANA that reacts with dsDNA, histones, and nucleosomes could mean lupus. However, some ANAs react against many other antigens.

Original Price: Rs. 300
Discounted Price: Rs. 200
The Ketone Bodies/ Acetone test is used to check the level of ketones in your urine. Normally, your body burns sugar for energy. But if you don't have enough sugar in your body for energy, your body burns fat instead and makes substances called ketones. The ketones end up in your blood and urine. It's normal to have a small amount of ketones in your body. However high ketone levels could result in serious illness or death. Checking for ketones keeps this from happening.

Original Price: Rs. 1000
Discounted Price: Rs. 800
A rubella blood test checks to see if you have antibodies to the rubella virus. Antibodies are proteins your immune system makes to help fight infections and keep you from getting sick. They're targeted to specific germs, viruses, and other invaders. Your doctor can tell a lot from the type of antibodies that you have in your blood. IgG stays in your bloodstream for life. It means you had either the illness or the vaccine in the past and are now immune to the virus. You're likely to have this test when you need to know that you can't get sick with rubella. You'll need both tests if you're pregnant and your doctor suspects you have rubella. And your baby will need both tests after birth, too.

Original Price: Rs. 1000
Discounted Price: Rs. 800
A rubella blood test checks to see if you have antibodies to the rubella virus. Antibodies are proteins your immune system makes to help fight infections and keep you from getting sick. They're targeted to specific germs, viruses, and other invaders. Your doctor can tell a lot from the type of antibodies that you have in your blood. IgM is first on the scene after you get rubella. It sticks around for 7 to 10 days in adults and up to a year in newborns. You'll get this test if your doctor thinks you may have rubella. You might need to have your blood tested in a public health lab in your state.

Original Price: Rs. 100
Discounted Price: Rs. 80
Routine urine cultures can look for a urinary tract infection (UTI) and see which germs are causing it. If germs are found, a urine culture can tell doctors what antibiotic will work best to treat the infection.





Original Price: Rs. 2500
Discounted Price: Rs. 2198
A lipoprotein (A) test measures the level of lipoprotein (A) in your blood.
Original Price: Rs. 700
Discounted Price: Rs. 600
It can detect cholestasis (blocked bile flow), liver tumors, or hepatitis.

Original Price: Rs. 6000
Discounted Price: Rs. 4999
Lipoprotein Panel Test: Lipoprotein panel assess cardiovascular risk more accurately than standard lipid profile.